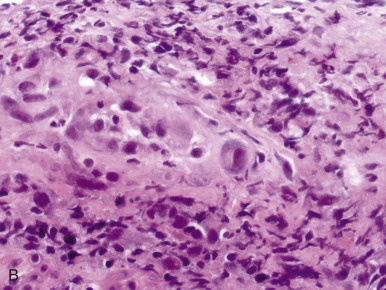
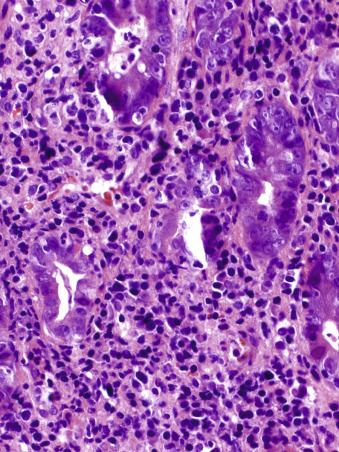

Introduction
The surgical pathologist plays a key role in the diagnosis of gastrointestinal infection. Virtually all types of pathogenic microbes can cause gastrointestinal infection, so the diagnostic pathologist must be cognizant of their varied histologic manifestations and acquainted with the complex morphologic features of viruses, bacteria, fungi, and parasites. Because certain noninfectious inflammatory conditions can mimic infection, recognizing their at times subtle distinctions is a critical aspect of the surgical pathologist's charge.
Infections of the Esophagus
Bacteria
Bacterial infection of the esophagus is uncommon; it is usually seen in neutropenic patients or as infection extending from the lung. Most cases occur after epithelial injury by acid reflux or previous viral infection. Neutropenia secondary to hematologic malignancy, intensive chemotherapy, or bone marrow transplantation predisposes to bacterial esophagitis.1 , 2 Approximately 15% of infectious esophagitis is seen in immunocompromised patients, but it is less common in patients with the acquired immunodeficiency syndrome (AIDS) than in the oncology setting because of the relative sparing of granulocyte counts in AIDS.3
Clinical symptoms include odynophagia, dysphagia, and retrosternal pain. Fever is reported in a minority of cases.2 , 4 Endoscopic findings are nonspecific and include mucosal friability, pseudomembranes, plaques, and ulcerations. Significant complications include perforation, fistula formation, and sepsis.5
The most common bacterial agents involved in gastrointestinal infection belong to the normal flora of the mouth and upper respiratory tract, including Staphylococcus aureus, Staphylococcus epidermidis, Streptococcus viridans, and Bacillus species. Polymicrobial infection is common.
Bacterial infection evokes a marked neutrophilic exudate, cellular necrosis, and degeneration (Fig. 9-1 ). In severely neutropenic patients, ulcers and pseudomembranes without substantial acute inflammation can be seen. Most bacteria can be identified in tissue sections by light microscopy with tissue Gram stain and oil immersion optics. The diagnosis of bacterial esophagitis is based on the presence of confluent bacteria invading subepithelial tissues (see Fig. 9-1B).2 Bacterial cultures of endoscopic biopsy samples are usually of little value due to bacterial contamination by the endoscope.
Figure 9-1.


Nonspecific bacterial esophagitis. A, Esophageal mucosa is replaced by cellular necrosis and a fibrinopurulent exudate. B, Brown-Hopps stain highlights bacteria in subepithelial tissues.
(Courtesy of Dr. Laura Lamps.)
Mycobacterium tuberculosis
Esophageal tuberculosis is usually caused by extension of infection from contiguous organs or from miliary spread. Autopsy studies show esophageal involvement in 0.15% of patients dying with tuberculosis. Primary esophageal tuberculosis is extremely rare.6., 7., 8. The most common symptoms of esophageal tuberculosis are dysphagia, weight loss, and retrosternal pain.9 Imaging modalities may show extrinsic compression by involved lymph nodes in the mediastinum, traction diverticula, stricture, kinking of the esophagus, sinus or fistulous tract, and pseudotumoral masses.10 Chest computed tomography and endoscopic ultrasonography reveal extrinsic nodular masses, consistent with mediastinal lymphadenopathy showing central hypodensity, rim enhancement, and calcification.6 , 11 Endoscopic examination shows shallow ulcers with smooth border, a gray purulent base, and irregularly infiltrated edges.12 , 13
The differential diagnosis includes carcinoma, fungal infection, syphilis, and Crohn disease.14 In some cases, no preoperative diagnosis is established before esophagectomy15 , 16; however, even if a developed stricture has formed, antimycobacterial treatment can successfully save the patient from a complex surgical intervention.17
The characteristic histologic features of esophageal tuberculosis include necrotizing, often confluent granulomas, which can be present at any level of the esophagus (Fig. 9-2 ). A rim of lymphocytes may be present at the periphery. In some cases, granulomas are sparse, or hyalinized and calcified. Acid-fast stains may demonstrate the organisms, but culture confirmation is often required.18 Polymerase chain reaction (PCR) for Mycobacterium tuberculosis can be a rewarding diagnostic approach.19., 20., 21., 22.
Figure 9-2.

Mycobacterium tuberculosis. Caseating granuloma involving esophageal wall.
Other granulomatous conditions, including mycobacterial infection due to Mycobacterium kansasii or Mycobacterium bovis, fungal infection, and Crohn disease, should be excluded. Features favoring Crohn disease include the presence of transmural lymphoid aggregates with deep fistulas and fissures.
Fungi
Fungal esophagitis is most frequently caused by Candida spp., but other pathogens, including Histoplasma, Aspergillus, Cryptococcus, Coccidioides, Paracoccidioides, Trichosporon, Blastomyces, and Mucor, can cause disease (Table 9-1 ). Fungal infection is often superimposed on other infections, and efforts at identifying all possible pathogens are mandatory to design optimal treatment. Debilitated and immunocompromised individuals are susceptible to fungal infections, and irradiation, chemotherapy, and chronic motility disorders are predisposing factors. Esophageal candidiasis is the most common cause of esophagitis in HIV-infected patients.23 , 24
Table 9-1.
Comparative Morphology of Candida, Aspergillus, and Histoplasma Species
| Organisms | Morphologic Features |
|---|---|
|
Mixture of budding yeast and nonbranching pseudohyphae; occasional septate (true) hyphae |
| Candida glabrata |
|
| Aspergillus species |
|
| Histoplasma capsulatum |
|
H&E, hematoxylin and eosin.
Candidiasis
Candida albicans is a constituent of normal flora. Whereas it primarily affects patients with predisposing conditions, Candida esophagitis can occur in apparently normal hosts. A variety of Candida species are pathogenic, including Candida glabrata, Candida parapsilosis, Candida tropicalis, Candida stellatoidea, and Candida krusei. Of those, C. tropicalis tends to be more virulent, showing a propensity to invade submucosal blood vessels.25 Patients with intact immunity usually develop inflammation at the infected site that limits penetration by the microorganisms.
Acute candidal esophagitis is the most common manifestation. Presenting symptoms are nonspecific and include odynophagia, dysphagia, and retrosternal chest pain. Esophageal bleeding, perforation, stricture, sinus formation (with secondary pulmonary abscess), extensive necrosis, and systemic invasion are rare.26 Subacute candidal esophagitis is an uncommon disease that usually affects asymptomatic and immunocompetent patients, but it can cause esophageal strictures and pseudodiverticula. It typically follows an indolent course. Chronic candidal esophagitis is also rare and is usually seen as a feature of chronic mucocutaneous candidiasis. These patients usually have other gastrointestinal manifestations, including malabsorption and loss of parietal cell function.27
Candidal infections can result in significant morbidity and death, especially in high-risk patients. Patients who receive radiation therapy to the thorax for lung or esophageal cancer or inhaled corticosteroid for asthma or chronic obstructive pulmonary disease are predisposed to candidal esophagitis.
Candidal infections yield small, yellow-white, raised plaques with surrounding erythema in mild disease—and confluent linear and nodular plaques or membranes covering a friable, erythematous, ulcerated mucosa in extensive disease—particularly in the middle and distal esophagus.26 Erosion, ulcers, and strictures can develop. Fungi are densely adherent to the inflamed mucosa. In advanced disease, the esophagus may become stenotic and show mucosal irregularities. In chronic cases, umbilicated, wartlike lesions may develop. The gross features are easily confused with pseudodiverticulosis, varices, or carcinoma. Rarely, fungal esophagitis leads to a botryoid appearance resembling clusters of grapes projecting from the mucosa, and. mucosal bridges may form. In severe candidiasis, necrosis of the entire esophageal mucosa may be seen.28
Candida species are characterized by a mixture of blastoconidial spores, 3 to 4 µm in diameter, and nonbranching pseudohyphae that may become quite large, up to 2 µm in diameter. True septate hyphae can also be seen. These structures are best seen with Grocott methenamine silver (GMS) or periodic acid–Schiff (PAS) stain, and the presence of all of these structures is diagnostic of Candida infection (Fig. 9-3 ). Isolated budding yeasts without pseudohyphae or evidence of tissue invasion are often seen in inflammatory exudates at the ulcer bed; however, pseudohyphae or true hyphae are required for accurate diagnosis. Superficial colonization, particularly of nonviable tissue, does not necessarily indicate clinically significant disease. Whereas cytologic brushings from the plaques are more sensitive for fungal detection, biopsies are required to ascertain whether the fungus has invaded tissue. For this reason, it is important to indicate in the pathology report the types of fungal forms that are present (yeast, pseudohyphae, or both) and whether they are only seen in exudates or actually invade tissue.
Figure 9-3.


A, Candidal esophagitis is characterized by a mixture of spores and nonbranching pseudohyphae that invade the superficial layer of squamous epithelium. B, A PAS stain highlights the fungal elements.
Candida infections also mimic other fungal infections, such as aspergillosis and histoplasmosis. Candida spp. can be differentiated from Aspergillus based on the width of hyphae, the presence of acute-angle dichotomous branching by Aspergillus spp., and the presence of blastoconidia in Candida infection. The presence of pseudohyphae in Candida generally differentiates it from Histoplasma capsulatum. But if only yeast forms are identified, the differentiation of Candida from Histoplasma may be difficult. However, tissue Gram stain almost always decorates the gram-positive yeast forms of Candida.
Aspergillosis
Aspergillus, which is a ubiquitous fungus, rarely causes esophagitis.29., 30., 31., 32. Several species can infect the esophagus, including Aspergillus fumigatus, Aspergillus niger, and Aspergillus flavus. Aspergillus commonly colonizes immunocompromised patients33., 34., 35. but can invade tissues and disseminate via the bloodstream, posing a life-threatening condition. Patients with esophageal aspergillosis present with painful or difficult swallowing and weight loss. Concurrent mucosal candidiasis may be present.
Esophageal aspergillosis typically involves the mucosa and extends into the muscularis propria. When vascular invasion occurs, thrombosis and subsequent infarction may lead to perforation. Cytologically, Aspergillus is characterized by the presence of acute-angle branching septate hyphae with smooth, parallel walls, ranging in size from 2 to 4 mm in diameter. Characteristic conidiophores are rarely seen in this setting. Aspergillus can be differentiated from Mucor by its uniform thickness, mode of branching, and presence of frequent septation.
Other Fungal Infections
Blastomyces, Histoplasma, Mucor, and Cryptococcus species rarely involve the esophagus,36 and usually only in patients with disseminated disease, but esophageal infection can arise from infections in contiguous structures, such as the lungs or mediastinum.30 Patients with histoplasmosis can present with dysphagia resulting from esophageal compression by infected mediastinal lymph nodes or as a complication of mediastinal granuloma or sclerosing mediastinitis. Mediastinal granulomas can cause traction esophageal diverticuli.36
Viruses
Herpes Simplex Virus Types 1 and 2
Herpes infection may be seen throughout the gastrointestinal tract but is usually limited to squamous epithelium–lined structures (e.g., esophagus, anorectum). Herpes esophagitis has been reported with both herpes simplex virus type 1 (HSV-1) and HSV-2,37 , 38 and it affects 0.5% to 6% of patients, primarily those who are immunocompromised due to AIDS, transplantation, or chemotherapy. However, immunocompetent adults and neonates also develop herpetic esophagitis.
Primary infections are common in neonates with disseminated HSV.39 In adults, the disease typically manifests as a reactivation of latent disease. Usually, a previously healthy, immunocompetent patient with a history of recurrent “cold sores” (i.e., nasolabial herpetic lesions) who presents with concurrent esophageal symptoms most likely has HSV esophagitis. In this setting, infections are self-limited. However, immunocompromised individuals may experience severe prolonged infections, and they are at risk for serious complications, including mucosal necrosis, hemorrhage, strictures, tracheobronchial fistula, and disseminated infection.40
The endoscopic appearance of HSV esophagitis varies with the time of infection. Early lesions consist of rounded, 1- to 3-mm, clear vesicles seen predominantly in the middle to distal esophagus. Subsequently, the epithelial roof is eroded to leave small, 1- to 3-mm ulcers. After most of the HSV-infected squamous cells have sloughed off, characteristic sharply demarcated ulcers with raised margins and a yellow-gray base are seen (Fig. 9-4 ). The uninvolved mucosa usually appears normal. If infection progresses, the ulcers may coalesce to produce inflammatory exudates that grossly resemble Candida esophagitis.41., 42., 43., 44.
Figure 9-4.

Gross appearance of esophageal ulcers due to herpes esophagitis in a patient with HIV infection. Numerous punched-out ulcers are present.
(Courtesy of Dr. Rhonda Yantiss.)
Typical histologic findings include focal ulceration, neutrophils in the lamina propria, and an inflammatory exudate with sloughed necrotic squamous cells. Aggregates of macrophages near the ulcer are characteristic of the inflammatory response.45 Diagnostic cytopathic changes include nuclear molding, multinucleated giant cells, ballooning degeneration, and eosinophilic type A intranuclear inclusions showing margination of chromatin (Fig. 9-5 ). Cowdry type B inclusions are more frequently seen than type A inclusions. The edge of the ulcer and the sloughed squamous cells are the best places to sample for identification of the characteristic cytopathic changes. Viral culture is more sensitive than microscopic examination for diagnosis of HSV infection, and the combination of directed brushings and biopsy specimens submitted for culture and histology improves the sensitivity of endoscopic diagnosis compared with biopsy alone.46 , 47 Accurate diagnosis can be confirmed in situ by immunostaining with commercially available specific monoclonal antibodies.
Figure 9-5.


Herpes simplex virus (HSV) esophagitis. A, A resection specimen shows a sharply demarcated ulcer with raised margins. The ulcer bed is partially covered by inflammatory exudate that contains sloughed squamous cells. B, HSV cytopathic changes consist of nuclear molding, multinucleated giant cells, and type A intranuclear inclusions with margination of chromatin.
The differential diagnosis of HSV esophagitis includes other viral infections such as cytomegalovirus (CMV) and varicella-zoster virus (VZV) infection. Their histologic features overlap, so immunostains and in situ hybridization are required to accurately distinguish them. It is important to distinguish HSV from other infections, because specific antimicrobial agents are required for effective treatment.
Multinucleated squamous epithelial giant cells that are located predominantly in the proliferative basal and suprabasal zones of the preserved squamous epithelium have also been reported in the setting of reflux esophagitis, radiation therapy, and drug esophagitis. The epithelial giant cells may be confused with herpetic infection; however, the former typically lacks ground glass nuclear inclusions and peripheral condensation of chromatin at the nuclear membrane. The multinucleated cells in herpes esophagitis are generally more prominent in the superficial aspects of the epithelium and in luminal inflammatory debris. An immunostain for herpes virus antigen can help to exclude HSV infection.48
Cytomegalovirus
Because CMV infection is a systemic infection that involves multiple organs in addition to the esophagus, the clinical presentation of CMV esophagitis is often distinct. The onset of symptoms is more gradual than that of HSV esophagitis and includes fever, epigastric pain, nausea, vomiting, diarrhea, and weight loss, as opposed to the painful difficulties in swallowing and retrosternal pain commonly seen in HSV infection.1., 49., 50. Endoscopically, CMV infection manifests as multiple, discrete, small, superficial ulcers in the middle or distal esophagus, but it may yield one or more large, flat, and elongated ulcers. Because HSV esophageal ulcers are rarely several centimeters in diameter, the presence of giant ulcers is suggestive of CMV esophagitis in patients with AIDS (Fig. 9-6A ), although HIV-associated idiopathic ulcers may also become large.51 Penetrating giant ulcers causing fistulas and pseudotumoral lesions may be seen in AIDS patients.5 CMV esophagitis may coexist with both HSV and Candida infection in transplant recipients and in AIDS patients.1 , 52
Figure 9-6.

Cytomegalovirus (CMV) infection of esophagus. A, A mucosal biopsy from a large ulcer in a patient with AIDS demonstrates granulation tissue replacing lamina propria, as well as thickened and inflamed muscularis mucosae. B, High-power magnification reveals an endothelial cell with CMV cytopathic changes.
CMV cytopathic effects typically develop in glandular epithelium, endothelial cells, and fibroblasts rather than in squamous cells (see Fig. 9-6). Therefore, superficial biopsy specimens that contain only squamous epithelium or brushings for cytology are usually insufficient for the evaluation of CMV infection, and it is recommended that biopsy include the granulation tissue of the ulcer bed. Classic cytopathic effects of CMV include intranuclear eosinophilic inclusions surrounded by a halo with margination of the chromatin to the nuclear membrane. In contrast to HSV and VZV, multiple small cytoplasmic inclusions may be seen with hematoxylin and eosin (H&E) stain, and to advantage with PAS and GMS. CMV can superinfect the ulcerations caused by HSV, and mixed infections are common in severely immunocompromised individuals (Fig. 9-7 ). Immunohistochemistry with specific antibodies or genetic probing for virus may be necessary to establish the diagnosis, especially if the patient has received antiviral agents prophylactically, because such agents can inhibit nuclear cytopathic changes.
Figure 9-7.



Mixed infection in a severely immunocompromised patient. The esophageal biopsy consisted of granulation tissue (A), with endothelial cells demonstrating characteristic cytomegalovirus cytopathic changes (inset), and detached fragment of fibrinopurulent exudate (B). C, Immunostain for herpes simplex virus (HSV) performed on deeper sections also revealed positive multinucleated cells consistent with HSV cytopathic changes.
Other Viral Infections
Primary VZV infection (chickenpox) in immunocompromised children is often associated with severe visceral dissemination and has a mortality rate of 7% to 30%.53 , 54 VZV esophagitis is rare and occurs in severely ill patients, but not in AIDS patients.3 VZV cytopathic changes are seen in epithelium, endothelium, and stroma cells and are indistinguishable from those of HSV.55 Cytoplasmic rarefaction and vacuolization of the infected cells, as well as dissociation of the basal layer from the lamina propria, may be observed. To differentiate VZV infection from HSV infection, immunohistochemical staining with specific monoclonal antibodies is required.
Esophageal infections with human papillomavirus (HPV) may manifest as erythematous macules, white plaques, nodules, exuberant frondlike lesions, or even ulcerations.56., 57., 58., 59. Large lesions can be mistaken for malignancy on endoscopic examination, and small lesions may be confused with glycogen acanthosis.60 Koilocytotic changes in squamous epithelium are characteristic. As in the cervix and anus, HPV infection is associated with well-defined papillomas (condylomas) and with mucosal hyperplasia.
Epstein-Barr virus (EBV) esophagitis is infrequently reported but can be seen in otherwise healthy patients with infectious mononucleosis. These patients present with odynophagia and hematemesis and develop multiple small (3-5 mm) midesophageal ulcerations that are deep and linear, with erythematous rims and a gelatinous base.61 Histologically, EBV-infected esophageal mucosa is comparable to oral hairy leukoplakia seen in AIDS patients; it is characterized by epithelial hyperplasia, parakeratosis, and koilocytosis.62 , 63 EBV infections confirmed by in situ hybridization are also seen in AIDS.63
Human Immunodeficiency Virus
Esophageal ulceration is an important cause of morbidity in patients with HIV/AIDS and may result from a variety of factors. A prospective study reported that 50% of esophageal ulcers in HIV-infected patients were caused by CMV infection, and about 40% were classified as idiopathic ulcers. Other causes included HSV infection, gastroesophageal reflux disease, and Candida infection. In 10% of patients, more than one etiology was discovered during long-term follow-up.64 Acute seroconversion to HIV can produce multiple small esophageal ulcers with an intense inflammatory infiltrate. Based on the ultrastructural detection of viral-like particles in biopsy samples, it was hypothesized that HIV was responsible for the ulcerations in these individuals.65 , 66
Large idiopathic esophageal ulcerations have been documented in 4% to 12% of HIV-infected patients with esophageal symptoms, especially those in late stages of AIDS.52 , 67 A thorough evaluation for other infectious agents was unrevealing.68 Some have suggested that HIV is causative, based on demonstration of HIV by in situ hybridization69 and positive immunohistochemistry and enzyme-linked immunosorbent assay (ELISA) for HIV p24 core protein in macrophages lining the ulcerations.70 , 71 However, HIV PCR was also positive in the majority of the examined patients with CMV esophagitis, and HIV can be cultured in about 50% of esophageal specimens from otherwise asymptomatic HIV-infected patients,72 raising doubt as to whether HIV is the cause of giant ulcerations. These patients may respond to systemic corticosteroid therapy,69., 71., 73., 74. but treatment also predisposes patients to infectious complications (Table 9-2 ).
Table 9-2.
Viral Pathogens of Esophagus
| Virus | Location | Macroscopic Features | Histology |
|---|---|---|---|
| HSV, VZV | Middle to distal esophagus not extending to stomach (usually involves squamous mucosa) | Multiple small, sharply demarcated and shallow ulcers | Epithelial ballooning and inclusions at ulcer edge; only inflamed granulation tissue in ulcer bed |
| CMV | Part of multiple organ involvement (stomach, intestine > esophagus) | Resembles HSV; occasionally one or more giant ulcers | Cytopathic effects involving endothelium, stromal cells, and/or submucosal glands; infection of squamous cells rarely seen |
| HPV | Esophagus occasionally involved | Normal, elevated lesions, or papillomas | Koilocytosis in squamous epithelium; condyloma, epithelial hyperplasia, or normal-appearing mucosa |
| EBV | Middle esophagus | Multiple small, deep, and linear ulcers | Similar to oral hairy leukoplakia; epithelial hyperplasia, parakeratosis, and koilocytosis |
| HIV | Esophageal involvement hard to document | Large ulcers or small ulcers resembling HSV | No specific changes |
CMV, cytomegalovirus; EBV, Epstein-Barr virus; HIV, human immunodeficiency virus; HPV, human papillomavirus; HSV, herpes simplex virus; VSV, varicella-zoster virus.
Infections of the Stomach
Given the protective mechanism of low ambient gastric pH, only a limited number of infectious agents can thrive in the stomach, usually as a result of a high infectious burden or specific evolved protective mechanisms. Not surprisingly, patients in immunodeficient states are at greater risk for infectious gastritis. Although Helicobacter pylori is the most common cause of infectious gastritis, other agents also cause disease (Table 9-3 ).
Table 9-3.
Pathogens Associated with Infectious Gastritis
| Etiology | Clinical Setting | Histology |
|---|---|---|
| Viruses | ||
| Cytomegalovirus | Immunocompromised patients
|
Erosive gastritis |
| Herpes simplex virus | ||
| Varicella-zoster virus | ||
| Bacteria | ||
| Streptococcus |
|
Necrotizing gastritis |
| Escherichia coli | ||
| Enterobacteriaceae | ||
| Staphylococcus aureus | ||
| Mycobacterium tuberculosis | Endemic area | Erosive and fibrosing gastritis with necrotizing granulomas |
| Helicobacter pylori | General population | Chronic active gastritis |
| Helicobacter heilmannii | ||
| Mycobacterium avium | AIDS | Ill-formed granulomas |
| Actinomyces | Suppurative and mass-forming gastritis | |
| Syphilis | Sexually transmitted disease | Diffuse inflammatory gastritis |
| Clostridium perfringens, E. coli, Streptococcus, Enterobacter, Pseudomonas aeruginosa |
|
Emphysematous gastritis |
| Fungi | ||
| Candida |
|
Aphthous, or linear ulcerations or even larger ulcers. |
| Histoplasma capsulatum |
|
Inflammatory mass. |
| Phycomycosis | Ulceration and hemorrhagic necrosis | |
| Parasites | ||
| Cryptosporidiosis | AIDS | Minimal inflammation |
| Strongyloides stercoralis | Immunosuppressed patient (e.g., AIDS, diabetes) | Diffuse mucosal involvement |
| Anisakiasis | Consumption of raw shellfish | Eosinophilic and granulomatous gastritis |
| Ascaris lumbricoides | Gastric outlet obstruction |
Viruses
Cytomegalovirus
Although CMV infection may occur in immunocompetent patients,75 gastrointestinal CMV usually occurs in immunocompromised individuals due to malignant disease, iatrogenic immunosuppression, or AIDS.76 In these settings, CMV infection can be life-threatening.
Clinical symptoms include epigastric pain, fever, and atypical lymphocytosis. Endoscopically, the gastric mucosa is congested and edematous, with multiple erosions and ulcerations.77 A pattern of hypertrophic gastritis resembling Ménétrièr disease and associated with protein-losing gastropathy has been described.78
The biopsy specimens demonstrate mixed inflammatory infiltrates with characteristically enlarged endothelial, stromal, or epithelial cells showing diagnostic owl's-eye intranuclear inclusions. However, cytopathic changes can be difficult to identify, and multiple granular basophilic cytoplasmic inclusions may be seen instead.79 It has been noted that inclusions are usually observed in the endothelial cells if the mucosa is not ulcerated. Alternatively, they are commonly seen in endothelial and stromal cells when the mucosa is ulcerated.80
Gastric involvement with HSV or VZV is rare. Reactivation of infection acquired at an early age is often the result of radiation therapy, chemotherapy, or malignancies in immunocompromised patients.81 Symptoms include nausea, vomiting, fever, chills, and fatigue. Gastroscopic examination shows multiple small ulcers, at times yielding a cobblestone appearance, with ulcerated plaques or linear superficial ulcers. Microscopic examination reveals epithelial cells with ground glass nuclei and eosinophilic intranuclear inclusions surrounded by a clear halo. Acute gastritis due to EBV has been reported but is rarely biopsied. The pathology is characterized by prominent lymphoid hyperplasia. Rare cases of acute measles gastric infection with giant cells of Warthin-Finkeldey type have been described.82
Bacteria
Acute Suppurative Gastritis and Emphysematous Gastritis
Acute suppurative gastritis is a rare disorder caused by bacterial infection of the submucosa and muscularis propria. In severe cases, necrotizing gastritis may result.83 It is associated with ethanol abuse, upper respiratory tract infection, AIDS and other immunocompromised states, and infected peritoneal-jugular venous shunts; it rarely occurs as a complication of surgical biopsy.84 , 85
Patients are acutely ill with acute upper abdominal pain, peritonitis, purulent ascitic fluid, fever, and hypotension. Ultrasonography and CT may establish the diagnosis.86 Gastroscopic examination reveals a thick and edematous gastric wall. The mucosa may be granular with a dark green exudate. The diagnosis is commonly delayed, and the mortality rate is high. Gastric resection combined with broad antibiotic therapy directed against the most common organisms is the treatment of choice.
Microscopic examination reveals an edematous submucosa with a brisk polymorphonuclear infiltrate and numerous gram-positive and gram-negative organisms. Offending organisms include streptococci as well as S. aureus, Escherichia coli, Enterobacteriaceae, and other gram-negative bacilli.87 Intravascular thrombosis is common, and extensive mucosal and mural necrosis can be seen.
Emphysematous gastritis is a rare variant resulting from infection by gas-forming organisms, most commonly Clostridium perfringens, E. coli, Streptococcus, Enterobacter, and Pseudomonas aeruginosa. Predisposing factors include gastroduodenal surgery, ingestion of corrosive material, gastroenteritis, and gastrointestinal infarction. In most cases, radiographic studies show gas bubbles conforming to the contours of the stomach.
Mycobacterium tuberculosis
Since the introduction of pasteurization, gastric infection due to M. tuberculosis has been rare; it is currently associated with pulmonary tuberculosis. The patient commonly presents with abdominal pain, nausea and vomiting, fever, and weight loss.
Endoscopic examination may demonstrate multiple bleeding ulcers or erosions; a narrowed, deformed antrum; and possibly gastric outlet obstruction due to a thickened wall. Microscopic examination may show an ulcerated mucosa, but the presence of necrotizing granulomas is diagnostic. The presence of acid-fast bacilli (AFB) can be confirmed on acid-fast staining,88 but PCR for M. tuberculosis can also be a contributory tool.
Although Mycobacterium avium complex (MAC) infection is common in AIDS patients, the stomach is rarely involved. Gastric MAC may be associated with refractory chronic ulcers. Presenting symptoms include fever, night sweats, anorexia, weight loss, diarrhea, and abdominal pain. Abdominal CT scans may show mesenteric lymphadenopathy.89 Microscopic examination shows a lamina propria expanded by numerous foamy histiocytes. These aggregate in ill-formed, non-necrotizing granulomas. AFB, often numerous, can be highlighted by Ziehl-Neelsen or Fite stain.
Actinomycosis
Primary gastric actinomycosis is a rare, chronic, suppurative disease. Symptoms include fever, epigastric pain, and bleeding. The stomach reveals a large, ill-defined ulcerative mass that mimics malignancy. Histologically, collections of neutrophils and sinuses are seen. Actinomyces, a gram-positive, filamentous, anaerobic bacterium, is best observed with a silver stain. The finding of sulfur granules containing long, filamentous, gram-positive bacilli is diagnostic.90
Syphilis
Syphilitic infection of the stomach is currently rare. Given the protean manifestations of this disease, gastric involvement in secondary or tertiary syphilis remains a diagnostic challenge. Endoscopic examination may show numerous shallow ulcerations with surrounding erythema, or a nodular mucosa with enlarged, thickened folds, suggestive of adenocarcinoma or lymphoma. Microscopic examination reveals severe gastritis with dense plasma cell infiltrates and varying numbers of neutrophils and lymphocytes. Gland destruction, vasculitis with endothelialitis, and ill-formed granulomas are seen. Warthin-Starry silver stain or modified Steiner stain may reveal numerous spirochetes. However, in many cases, immunofluorescence studies and PCR are required to establish a definitive diagnosis (Figs. 9-8 and 9-9 ).91
Figure 9-8.

Syphilitic involvement of stomach. The mucosa is markedly thickened, and the normal architecture is effaced by a lymphoplasmacytic infiltrate (inset).
Figure 9-9.

Syphilitic involvement of stomach. Immunofluorescence demonstrates numerous Treponema pallidum.
Fungi
Fungal colonization of the stomach may be seen in patients with underlying malignancy or in immunocompromised patients treated with antibiotics or corticosteroids. Candida infection also occurs in alcoholic patients and in those who have ingested corrosive chemicals. The organisms can be found on H&E-stained sections but are more readily seen with PAS with diastase or silver stains. The mucosa shows multiple, aphthous, and linear ulcerations, or single or multiple larger ulcers. Microscopically, the superficially necrotic, fibrinopurulent mucosa is infiltrated by yeast and pseudohyphae.
Fungal contamination of peptic gastric ulcer with Candida species is not uncommon and is likely of limited clinical significance, although it remains a matter of debate. These ulcers tend to be larger and are more often suspected of being malignant.92
Gastric histoplasmosis is a rare condition that manifests with hypertrophic gastric folds or masses mimicking adenocarcinoma. Biopsy shows intense infiltration by macrophages containing H. capsulatum. Fatal hemorrhage from gastric ulcer has been reported.93
Gastric phycomycosis is rare and highly lethal. It is classified as either invasive or noninvasive. The former type is characterized by deep invasion of the gastric wall and blood vessels. Ulceration and hemorrhagic necrosis of the mucosa and wall, with infiltrating pigmented nonseptate hyphae, are seen.94
Parasites
Gastric parasitic infections are rare and are reported in specific clinical settings. Cryptosporidiosis, for example, has been reported in AIDS patients.95 , 96 The stomach is rarely affected by Strongyloides stercoralis, although colonization of peptic ulcers has been reported, and diffuse mucosal involvement may be seen in immunosuppressed patients. On biopsy, the parasite is easily identified infiltrating the mucosa.97
Gastric invasive anisakiasis is commonly acquired after ingestion of raw shellfish containing the nematode larvae of Anisakis, although cases caused by Pseudoterranova spp. have also been reported in the United States. Typically, patients present with epigastric pain as the parasite migrates into the gastric wall. Mild peripheral blood eosinophilia is not universal. Small hemorrhagic erosions are detected endoscopically, and microscopic examination shows either a phlegmonous reaction or an eosinophilic abscess with granulomatous features. The offending nematode larvae of Anisakis can be identified based on the presence of characteristic Y-shaped lateral cords and a Y-shaped intestinal lumen at midsection (Fig. 9-10 ).98 The lateral cords of Pseudoterranova are characteristically butterfly-shaped. Both lack the lateral alae of Ascaris larvae.
Figure 9-10.

Anisakiasis. The helminth displays characteristic Y-shaped lateral cords (arrowhead).
Rare examples of gastric infection by Ascaris lumbricoides have been reported in association with outlet obstruction caused by adult worms.99
Helicobacter pylori–associated Chronic Gastritis
H. pylori is a gram-negative rod that has a propensity to infect the gastric mucosa. H. pylori are 3.5-µm long and generally comma-shaped or slightly spiral in form.100 The infection is usually acquired in childhood and causes chronic gastritis if the organisms are not eradicated. The majority of infected patients carry and transmit H. pylori without any symptoms. The prevalence of the infection varies worldwide, ranging from less than 15% in some cohorts to almost 100% in underdeveloped countries.101 , 102 Currently, despite a decrease of infection worldwide, at least 50% of the world's population is actively infected. The infection is transmitted by close personal contact.
H. pylori produces active and chronic gastritis. The lamina propria is expanded by a mononuclear cellular infiltrate, lymphocytes, and plasma cells, and lymphoid aggregates and follicles can also be seen (Figs. 9-11 and 9-12 ). If lymphoid inflammation is prominent, the term follicular gastritis has been adopted.103 Normally, lymphocytes rarely enter the epithelium. Various degrees of neutrophilic infiltrate, reported as evidence of activity, may be seen. There are significant variations among infected individuals, based on host factors and the strain of infection.104 , 105 H. pylori swim freely within the gastric mucus layer that overlays the apical side of the gastric surface cells, as well as in the foveolae.105 In patients taking proton pump inhibitors, the organism translocates deep into the gastric glands (Fig. 9-13 ). Whereas H. pylori–induced damage is related to humoral and cell-mediated immune mechanisms, the morphologic activity varies significantly, from mild, with rare neutrophils seen, to severe, with glandular microabscesses.
Figure 9-11.

Helicobacter pylori infection. Low magnification of antral mucosa reveals a superficial band of dense chronic inflammation that is characteristic.
Figure 9-12.
Helicobacter pylori gastritis. A dense lymphoplasmacytic infiltrate is seen around the foveolae, together with scattered neutrophils.
Figure 9-13.

Helicobacter pylori infection of fundic mucosa. This is the characteristic appearance in a patient receiving proton pump inhibitor therapy without eradication of the bacteria.
H. pylori–associated chronic gastritis includes a heterogeneous group of clinical and pathologic changes. The most common phenotype observed at our institution is a mild antral gastritis or pangastritis with limited disruption of gastric acid secretion and usually no symptoms. A second syndrome, the duodenal ulcer phenotype, shows a marked antral gastritis with high gastric secretion and preserved fundic mucosa. The patients commonly experience symptoms of duodenal ulceration.
Although about 10% of infected patients experience spontaneous regression,106., 107., 108. in most cases gastritis progresses with time, yielding the gastric cancer phenotype. In this stage, the gastric mucosa typically undergoes changes that include glandular atrophy and intestinal metaplasia of the body fundus mucosa, accompanied by hypochlorhydria or achlorhydria. These changes increase the risk of gastric dysplasia and carcinoma. It has been calculated that patients with chronic atrophic gastritis have up to a 16-fold increased risk of developing gastric cancer. They are also at risk for development of mucosa-associated lymphoid tissue (MALT) lymphoma (extranodal marginal zone B-cell lymphoma).
In most cases, H. pylori can be identified in H&E-stained sections, although special stains (e.g., Giemsa, silver stains) and specific immunohistochemistry can aid in the detection of bacteria (Fig. 9-14 ).
Figure 9-14.

Silver stain demonstrating numerous curved Helicobacter pylori.
Helicobacter heilmannii is a rare cause of diffuse, antral-predominant gastritis. The organism, in the past reported as Gastrospirillum hominis, is larger than H. pylori and shows corkscrew-like spirals. H. heilmannii infection has been associated with the development of MALT lymphoma but not with gastric cancer. Special stains used for H. pylori also highlight this organism (Fig. 9-15 ).109., 110., 111.
Figure 9-15.


Helicobacter heilmannii. The thick, elongate, corkscrew bacteria are demonstrated in H&E-stained section (A,arrow) and with thiazine stain (B).
Infections of the Small Bowel
Bacteria
Escherichia coli
Although most E. coli strains are harmless, some can cause serious food poisoning. The harmless strains belong to the normal intestinal flora and benefit the host by producing vitamin K2 112 or by preventing the establishment of pathogenic bacteria within the intestine.113 , 114 Virulent strains of E. coli that can cause gastroenteritis are classified on the basis of serologic characteristics and virulence properties. These are enterotoxigenic E. coli (ETEC), enteropathogenic E. coli (EPEC), enteroaggregative E. coli (EAggEC), enteroadherent E. coli (EAEC), enteroinvasive E. coli (EIEC), and enterohemorrhagic E. coli (EHEC). Of these, ETEC and EAggEC are noninvasive and induce diarrhea by producing enterotoxins or a hemolysin or both. EAEC are non toxigenic and noninvasive115; they avidly adhere to the epithelial brush border by means of specific receptors. Therefore, the histology of the intestine in infected individuals is often normal. Conversely, EPEC, EIEC, and EHEC are invasive. ETEC, EPEC, EAggEC, and EAEC colonize the small intestine. EIEC and EHEC preferentially colonize the large intestine before causing diarrhea. In this section, only the histology of EPEC is described.
Enteropathogenic Escherichia coli
EPEC is a leading cause of infantile diarrhea in developing countries, and some types of EPEC are also an important cause of traveler's diarrhea. The mucosal biopsy reveals moderate to severe damage with irregular atrophy of surface epithelium and subnuclear vacuolization of crypt epithelium. Ultrastructural study reveals bacteria adherent to mucosal cells with flattening of microvilli, loss of the cellular terminal web, and cupping of the plasma membrane around individual bacteria—characteristic attachment–effacement lesions.116
Salmonella
Salmonella typhi usually causes a mild, self-limited illness, but the elderly, infants, and immunocompromised patients may develop a serious course with sepsis and death. Nontyphoid species (Salmonella paratyphi, Salmonella enteritidis, Salmonella typhimurium, Salmonella muenchen, Salmonella anatum, and Salmonella give) infections result in milder, self-limited gastroenteritis.
Based on a study that examined intestinal function and jejunal biopsy specimens obtained soon after the recovery phase from acute disease in 29 patients with Salmonella infection, normal or near-normal small-intestinal histology was seen in more than 90% of cases, despite defective absorption, which was transiently observed in 50%. The remaining patients developed partial villous blunting with increased inflammation in the lamina propria and surface epithelium associated with reactive epithelium.117 If the disease manifests with severe gastrointestinal bleeding that requires surgical intervention, Salmonella spp. commonly involve the ileum and cecum. In these cases, the bowel wall is thickened, and the mucosa displays erosions and ulcers that can be aphthous, linear, discoid, or full thickness in nature (Fig. 9-16A ). Perforation with or without fistula formation may be seen.118
Figure 9-16.


A, Opened, formalin-fixed specimen of terminal ileum from a patient with typhoid fever, showing ulceration of the Peyer patches. B, Low-power magnification of the ileum reveals diffuse inflammatory infiltrate transmurally involving the intestinal wall with surface ulceration, as well as nodular lymphoid aggregates.
Microscopically, there is ileal and cecal mucosal thickening resulting from a predominantly monocytic infiltrate. Low-power examination shows nodular and diffuse areas of infiltration, with the latter present predominantly at the center of the lesion (see Fig. 9-16B). The nodules are of two types. The first is a germinal center rimmed by a ragged and compressed mantle zone. The second and predominant type of nodule consists of uniform sheets of monocyte-macrophages with numerous apoptotic bodies and cellular debris, surrounded by small lymphocytes. The centers of these monocytic-rich foci consist of amorphous eosinophilic debris and degenerating cells.
The interfollicular and diffuse areas are replaced by phagocytic monocytes showing round to irregularly shaped nuclei and intermingled with small mature lymphocytes. Neutrophils are rare, even in the areas of mucosal ulceration. The inflammatory process breaches the muscularis propria and may extend into the serosa. Small mucosal erosions in uninvolved portions of the ileum reveal a predominantly lymphoid infiltrate with germinal center formation and clusters of monocyte-macrophages, most likely representing early lesions.118
The regional lymph nodes show a necrotizing lymphadenitis and marked sinusoidal and paracortical expansion due to a proliferation of monocyte-macrophages identical to those seen in the intestine. Subcapsular sinuses are distended by monocytes but may be compressed or obliterated. Actively phagocytic macrophages are seen, many containing intracellular apoptotic bodies and cell fragments. The necrotic foci tend to be rounded and rimmed by foamy macrophages that blend smoothly with the reminder of the node.118
The closest mimic of S. typhi enterocolitis is Yersinia infection.119., 120., 121. In both lesions, the terminal ileal mucosa and mesenteric lymph nodes are distorted by lymphoid and histiocytic hyperplasia; however, deep, penetrating ulcers and abundant epithelioid granulomas are characteristic features of Yersinia infections and not of S. typhi enterocolitis.
Also in the differential diagnosis, especially of the nodal involvement, are histiocytic necrotizing lymphadenitis (Kikuchi-Fujimoto disease) and sinus histiocytosis with massive lymphadenopathy (Rosai-Dorfman disease). These entities; however, rarely involve the intestine in a primary fashion.118
Vibrio
Eleven Vibrio species are recognized to cause human infection.122., 123., 124., 125., 126., 127. Infection with Vibrio cholerae results in cholera, an important cause of watery diarrhea and dysentery that may lead to significant dehydration and death. Although the disease is widespread, the role of intestinal biopsy is limited, because V. cholerae is a noninvasive, toxin-producing organism that causes minimal or no histologic changes. The intestinal mucosa appears to be intact, with mucin-depleted, dilated crypts in a background of edematous lamina propria with vascular dilatation and no significant inflammation. Ultrastructural examination reveals widening of the intercellular spaces and alteration of apical junctional complexes prominently in the villus epithelium, whereas blebbing of the microvillus border and mitochondrial changes occur in the crypt epithelium. The extent of the changes correlates with clinical severity.128
Clostridium
Clostridial infections are discussed more extensively in the infectious colitis section. Only a unique form of clostridial infection of the small intestine, enteritis necroticans, is discussed here.
Enteritis necroticans is a life-threatening infectious disease caused by C. perfringens, type C, a β-toxin–producing strain. It is characterized by segmental necrosis of the proximal jejunum and a high mortality rate if not diagnosed early and appropriately treated. In addition to antibiotics, advanced cases require surgical resection of necrotic bowel. The disease was first reported as Darmbrand (burnt bowels) in Northern Germany after World War II, where starved children and adults developed it after ingestion of large meals of meats and vegetables. It was prevalent between 1944 and 1948 but then disappeared in Europe as the nutritional status of its population improved. In 1963, a similar disease was reported from the Highlands of Papua New Guinea, where predominantly male children and young adults presented with severe abdominal pain after ceremonial feasting on large amounts of sweet potatoes and inadequately cooked pork contaminated with pig intestine. It was termed “pigbel,” a pidgin English term for abdominal pain following a pig feast. Nowadays, enteritis necroticans is rarely seen in developed countries, and the majority of affected subjects are diabetics.129 , 130 An impaired ability to degrade exogenous toxins due to decreased secretion of pancreatic protease in diabetics and individuals on low-protein diets, or the presence of natural protease inhibitors in sweet potato or soybean flour, together with delayed transit through the small intestine, may contribute to this unique form of clostridial infection.129
Histopathologically, the lesion starts abruptly in the proximal jejunum and usually extends distally to the ileum and cecum. Affected bowel segments are dilated, edematous, markedly congested, and thickened. Unaffected skip segments may be seen. Sloughing of the necrotic mucosa leaves severely ulcerated lesions, and transmural inflammation may be seen in severe cases.
The pathology varies depending on the severity and duration of disease, but common findings include severe mucosal necrosis with or without pseudomembrane formation, marked submucosal edema and hemorrhage, and fibrinous or fibrous serosal exudate (Fig. 9-17 ). Pneumatosis may be observed. The necrosis tends to be more prominent at the crown of plicae circulares, whereas the mucosa may appear normal at the vale of plicae circulares.130 The necrotic mucosa is often covered by large numbers of club-shaped, gram-positive rods, ranging in length from 0.5 to 1.2 µm. Immunohistochemistry or PCR for the α and β toxins of C. perfringens, type C (designated cpa and cpb, respectively) confirms the diagnosis.129 , 130
Figure 9-17.


Enteritis necroticans.A, Severe mucosal necrosis. B, The necrotic mucosa is covered by numerous club-shaped, gram-positive rods.
(Courtesy of Dr. Elena Brachtel.)
Yersinia
The genus of Yersinia includes three species that are pathogenic for humans and rodents: Yersinia pestis (the causative agent of plague), Yersinia enterocolitica, and Yersinia pseudotuberculosis. These enteropathogens most often cause self-limited enterocolitis and mesenteric lymphadenitis in humans.131 An acute abdomen presentation due to acute gastroenteritis, colitis, or pseudoappendicitis resulting from acute terminal ileitis is the most characteristic manifestation of the disease. Patents with iron overload,132., 133., 134. those receiving desferrioxamine,135., 136., 137. those with liver disease,133 and those who are immunocompromised or debilitated138 are at increased risk for severe disease. Yersinia can occasionally cause extraintestinal manifestations such as arthritis and erythema nodosum,135., 136., 137. as well as fulminate septicemia and peritonitis.132., 133., 134., 139.
Enteropathogenic Yersinia strains have a tropism for lymphoid tissue.140 Bacteria bind to and invade M cells within the epithelium overlying the lymphoid follicles of Peyer patches.141 , 142 Following their entry into the Peyer patches, the bacteria induce a host immune response characterized by infiltration of neutrophils and macrophages.143 Because of its lymphoid tropism, Yersinia infections preferentially involve the ileocecal and appendiceal regions, although any segment of the small or large intestine can be affected.144 The intestinal wall is congested and edematous. Diffuse or focal aphthous mucosal ulcers can develop. The serosa appears dull and hyperemic. Enlarged lymph nodes contain yellowish microabscesses that may become matted.
Microscopically, severe active enteritis with cryptitis, crypt abscesses, and ulceration can be seen in both Y. enterocolitica and Y. pseudotuberculosis infections. Crypt hyperplasia occurs throughout the small intestine, with villous atrophy.120 Sharply demarcated areas of lymphoid hyperplasia contain prominent germinal centers. The follicular ileitis may persist for months. Notably, the mucosa overlying the follicles develops small, punctate, aphthoid ulcers resembling the early mucosal lesions of Crohn disease.120 The ulcers are covered by fibrinopurulent exudates and large numbers of gram-positive coccobacilli. Epithelioid granulomas with central necrosis and prominent lymphoid cuffing are usually present in the mucosa, submucosa, and lymph nodes but can be seen on the serosa and lymph nodes as well (Fig. 9-18 ). The muscularis propria and serosa may be infiltrated by mixed inflammatory cells including eosinophils. Acute vasculitis as well as intussusception has been reported to cause segmental bowel ischemia.
Figure 9-18.

Yersinia infection. Epithelioid granulomas surrounded by prominent lymphoid infiltrate are seen in the deep mucosa and submucosa.
(Courtesy of Dr. Laura Lamps.)
The differential diagnosis includes Crohn disease, and this can be difficult to distinguish on histologic grounds alone. Cultures requiring special media,144 serologic titers, and PCR assays must be considered in the evaluation of a patient for inflammatory bowel disease (e.g., Crohn disease), or a patient with suspected inflammatory bowel disease for whom steroid therapy has failed, before more aggressive immunosuppressive therapy is elected.144 Features favoring a diagnosis of Crohn disease include crypt distortion, hyperplasia of the muscularis mucosa, and prominent neural hyperplasia; these features are evidence of chronic changes.
Mycobacterium tuberculosis
In accord with the distribution of lymphoid tissue, the ileocecal region is affected in 90% of patients infected by M. tuberculosis who present with gastrointestinal involvement. Grossly, intestinal tuberculosis displays an ulcerative, hypertrophic, or mixed pattern. The ulcerative form is present in most cases and exhibits multiple superficial ulcers. Patients with this morphology tend to have a virulent clinical course with high mortality. The hypertrophic form is least common and mimics Crohn disease because of its scarring, fibrosis, and heaped-up mass lesions.145 In the ulcerohypertrophic form, the intestinal wall becomes thickened and ulcerated by an inflammatory mass centered on the ileocecal valve.146 In this form, the ileocecal valve is frequently obscured by a mass consisting of mesenteric fat, fibrotic tissue, and inflamed lymph nodes.
Tubercles begin in the Peyer patches or lymphoid follicles, giving the mucosa a cobblestone appearance. As disease progresses, they involve the entire intestinal wall with multiple nodules that may also produce serosal and mesenteric “studs.” The ulcerative form of the disease begins as ragged ulcers that are varied in number and size. In contrast to Crohn disease, tuberculous ulcers are circumferential, with a long axis perpendicular to the lumen; fissure formation that extends into the muscularis propria may be seen.145 The ulcers may contain AFB, even in the absence of granulomas. The mucosa appears edematous and hemorrhagic.
Hypertrophic lesions are caused by pronounced intramural thickening with ulceration and obstruction. Ulcers heal with fibrosis, strictures, and stenosis that may be broad, at times several centimeters in length. Epithelioid granulomas with obvious caseation (Fig. 9-19 ) occur more frequently in ulcerative than in hyperplastic lesions and are distributed throughout the entire thickness of the intestinal wall. Regional mesenteric lymph nodes become enlarged and contain areas of caseous necrosis as well.
Figure 9-19.



Mycobacterium tuberculosis of terminal ileum and ileocecal valve demonstrating ulcers that are circumferential, with their long axis perpendicular to the lumen (A). B, The intestinal wall is thickened by epithelioid granulomas, lymphoid aggregates, and fibrosis. C, High power reveals caseous necrosis and epithelioid histiocytes.
(Courtesy of Dr. Sachiko Minmiguchi.)
Isolated organisms can be visualized in the granulomas and lymph nodes with the use of special stains and are recoverable in tissue culture. However, it is often difficult to detect the bacteria in suspected cases of tuberculosis, even with AFB-stained sections, due to the scarcity of the organisms. In this setting, the detection of mycobacterial DNA in formalin-fixed paraffin-embedded tissue by duplex PCR reactions can confirm the diagnosis. Other mycobacteria (e.g., M. kansasii, M. bovis) can produce similar pathologic features.
Although tuberculosis classically produces granulomas, other causes include fungal disease and Crohn disease. The latter may be difficult to distinguish from tuberculosis; transmural lymphoid aggregates, deep fistulas, and fissures favor Crohn disease (Table 9-4 ).
Table 9-4.
Causes of Granulomas in Small Intestine
|
Mycobacterium avium-intracellulare Complex
MAC is an AIDS-defining opportunistic infection. Disseminated MAC infection is usually seen in patients with advanced HIV infection, generally those with CD4-positive T-lymphocyte counts lower than 50 cells/µL, and is associated with significant morbidity and mortality.147 , 148 Since the induction of antimicrobial prophylaxis and highly active antiretroviral therapy (HAART), the incidence of disseminated MAC infection has dramatically declined, leading to improved survival.149
Disseminated MAC infection results from a primary infection, and a common portal of entry for MAC infection in AIDS patients appears to be the gastrointestinal tract.150 The mycobacteria penetrate the gastrointestinal mucosa by yet undetermined mechanisms. This occurs rapidly, and solitary organisms can be seen in the lamina propria without apparent mucosal abnormality. Mycobacteria within the lamina propria are phagocytosed by macrophages, but intracellular killing does not occur. Instead, the macrophages become stuffed with organisms as they multiply intracellularly. With continued bacterial replication, the host cell ruptures. This process leads to the presence of sheets of macrophages laden with AFB. Unimpaired replication of mycobacteria results in massive thickening of the intestinal wall,151 and infection spreads via mural lymphatics to involve lymph nodes. Mycobacteria replicate in the lymph nodes as well, and eventually the normal histology of the lymph nodes is effaced. Hematogenous dissemination occurs concurrently. Reticuloendothelial organs such as the liver, spleen, and bone marrow are the most frequent distant sites.150
The common presenting symptoms include diarrhea, fever, weight loss, and abdominal pain. Gastric ulcer, enterocolitis, enteric fistulas, intra-abdominal abscesses, and hemorrhage can also be seen as gastrointestinal manifestations.152 Intussusception secondary to hyperplasia of Peyer patches can occur, and clinical and radiologic pictures resembling ileal Crohn disease may also be observed. The duodenum is most frequently involved, followed by the rectum, ileum, colon, esophagus, jejunum, and stomach, for reasons that are uncertain. On endoscopic examination, multiple raised, yellow-white nodules are seen in the duodenum, but the mucosa may appear normal. Other endoscopic findings include, in descending order, ulceration, erythema, edema, friability, confluent nodules, and strictures.152
Biopsy of nodular lesions reveals atrophic mucosa with villous blunting, as well as widening of lamina propria by an infiltrate of plump macrophages exhibiting granular foamy cytoplasm (Fig. 9-20 ). However, the overall architecture of the intestine is usually preserved. Other inflammatory cells, such as lymphocytes, plasma cells, and neutrophils, are sparse, if present. Regional lymph nodes display comparable infiltrates. Epithelioid granulomas are rarely seen151; if present, they are poorly circumscribed and rarely contain multinucleated giant cells. Small areas of necrosis are present in up to 30% of cases.153 If necrosis is marked, the infiltrates are easily recognized on H&E stain even on low-power magnification. However, detection of focal involvement may require special stains. In addition to Ziehl-Neelsen and Fite stains, the PAS stain highlights mycobacteria. In contrast to M. tuberculosis infection, mycobacteria are usually present within macrophages, and not in giant cells or areas of caseous necrosis.
Figure 9-20.


Mycobacterium avium-intracellulare complex infection. A, Intestinal villi are obliterated by infiltration of numerous plump macrophages with foamy cytoplasm in the lamina propria. B, The lamina propria macrophages are filled with PAS-positive mycobacteria.
Whipple Disease (Tropheryma whippelii)
Whipple disease is a multisystem disease that results from infection with a gram-positive rod-shaped bacterium, Tropheryma whippelii. It is a rare disorder, and only about 1000 cases have been reported to date. Although it occurs in people of all ages, the typical patient is a middle-aged white man.154 T. whippelii appears to be present in the general environment, although neither its source nor its mode of transmission is well established. Since an association between Whipple disease and Giardia lamblia infection has been reported, it is plausible that both microorganisms occupy the same ecologic niche.155 Considering that many people may be exposed to T. whippelii but the disease develops in only some of them, it is likely that undefined predisposing immune factors exist.156
Several studies have demonstrated defective function of macrophages, with inability to degrade bacterial antigens efficiently, most likely due to inadequate production of interleukin-12 (IL-12),157 which may lead to diminished production of interferon-γ by T cells and defective macrophage activation. A decrease in IL-12 production may prevent the development of an effective type 1 helper T-cell immune response and favor a shift toward a type 2 helper T-cell response. Replication of T. whippelii in macrophages is associated with apoptosis of the host cell that correlates with the expression and release of IL-16.158
Whipple disease is characterized by two stages: a prodromal stage and steady-state stage. The prodromal stage is marked by protean symptoms, along with chronic nonspecific findings, mainly arthralgia and arthritis. The steady-state stage is characterized by weight loss, diarrhea, or both, and occasionally by other manifestations affecting the many organs frequently involved.159 The average time between the prodromal and the steady-state stage is 6 years. Patients on immunosuppressive therapy, such as corticosteroids or tumor necrosis factor antagonists, may experience more rapid clinical progression.160 , 161
Whipple disease frequently involves the small intestine, and jejunum and ileum more often than duodenum.162 On endoscopic examination, pale yellow, shaggy mucosal changes, attributed to lipid deposits, alternating with eroded, erythematous, or mildly friable mucosal patches, are often seen in the distal aspect of the duodenum and jejunum.163 , 164
The histologic hallmark of Whipple disease is the presence of macrophages with cytoplasmic PAS-positive, diastase-resistant granules or sickle-form particles; these are known as sickle-form particle-containing cells, or SPC cells. Bacilli may also be seen within and between epithelial cells, especially before the initiation of antimicrobial therapy.164 The intestinal villi are blunted and distorted by the collections of macrophage. In severe cases, subtotal or total villous atrophy can be seen. Conversely, the villous architecture is relatively normal in about one fifth of the cases.164
The majority of macrophages accumulate in the lamina propria of the villi, just beneath the luminal epithelial basement membrane (Fig. 9-21 ). A small number of macrophages may also be seen in the pericryptal lamina propria or submucosa or both.164 Lymphocytes, neutrophils, eosinophils, and plasma cells can be seen infiltrating among the macrophages. Although rare, non-necrotizing granulomas composed of epithelioid cells, which are PAS-negative in 40%, may be present in the mucosa, lymph nodes, and other organs, resembling sarcoidosis.163., 165., 166. Lymphatic obstruction can cause dilatation of lacteals and can produce lipid deposits in the mucosa.
Figure 9-21.




Whipple disease involving duodenum. A, A mucosal biopsy demonstrates partial villous blunting by collections of macrophages in the lamina propria. B, A large number of macrophages have accumulated in the lamina propria beneath the luminal epithelial basement membrane. C, PAS stain highlights intracytoplasmic granular particles that are resistant to diastase. D, Electron micrograph shows intact bacilli with characteristic thick walls and intracytoplasmic vacuoles.
Antimicrobial treatment may affect the histology of the disease. With a decrease in the number of PAS-positive macrophages, a change occurs in the pattern of mucosal involvement. It may go from diffuse to patchy; the distribution of macrophages may shift from the villous interstitium to the pericryptal interstitium; and the intensity of PAS-positive staining may diminish.163
Other entities can yield PAS-positive macrophage collections in the intestinal lamina propria. These include M. avium-intracellulare infection, histoplasmosis, chronic granulomatous disease, xanthomas, storage disease, and common variable immunodeficiency. Although the macrophages may appear similar in these conditions, lipid deposits are seen only in Whipple disease. As for differentiating Whipple disease from MAC infection, acid-fast staining occurs only with MAC. Because characteristic histologic features are seen in only 90% of patients,163 PCR assay is required to confirm the diagnosis in clinically suspicious cases that show nondiagnostic histologic changes (Table 9-5 ).
Table 9-5.
Comparison of Mycobacterium avium-intracellulare Infection and Whipple Disease
| M. avium-intracellulare | Whipple Disease | |
|---|---|---|
| Distribution in small intestine | Duodenum > ileum > jejunum | Jejunum and ileum > duodenum |
| Macroscopic features | Yellow-white nodules or normal | Erythema alternating with pale yellow, shaggy mucosal changes |
| Villous architecture | Blunted or normal | Blunted |
| Lacteals | Not dilated | Dilated |
| Lipid deposits | − | + |
| PAS stain | + | + |
| AFB stain | + | − |
AFB, acid-fast bacilli; PAS, periodic acid–Schiff.
Tropical Sprue
Tropical sprue is an intestinal malabsorption syndrome that affects residents and visitors to the tropics, including Puerto Rico, the Caribbean, northern South America, West Africa, India, and southeast Asia.167 Although its etiology and pathogenesis remain unclear, an infectious cause is strongly suspected because of the occurrence of tropical sprue particularly in rural areas with poor hygiene, susceptibility of visitors from developed countries in endemic regions,168 and a favorable response to antibiotic therapy.169 Patients also have been shown to have aerobic bacterial contamination of the small bowel, although no specific microorganisms are common to all patients.170 In addition, preexisting prolonged orocecal transit time may contribute to the disease process in some patients.170 Diagnostic evaluation of tropical sprue requires its differentiation from infectious etiologies, especially parasitic diarrheal diseases and Whipple disease, and from other malabsorption syndromes such as celiac disease. Jejunal biopsies are necessary to establish the presence of characteristic histologic features and to exclude other diseases.
Histologic features of tropical sprue consist of villous atrophy, crypt hyperplasia, chronic inflammatory cell infiltration (particularly plasma cells, lymphocytes, eosinophils, and histiocytes), and increased numbers of intraepithelial lymphocytes. Nuclear-cytoplasmic maturational dissociation (i.e., nuclear enlargement and decreased mitotic figures) may be observed in the enterocytes.171 , 172 The histologic findings, although similar to those of celiac disease, are not identical, and total villous atrophy is rare (<10%) in tropical sprue.173., 174., 175.
The disease first involves the jejunum, then spreads distally to the ileum. In the early stage, the mucosa may appear normal or may show only increased numbers of intraepithelial lymphocytes. In well-established disease, the pathologic changes become equally prominent in the ileum.175 Conversely, celiac disease commonly shows prominent mucosal changes in the proximal small intestine. This difference in disease distribution explains the more common association of tropical sprue with megaloblastic anemia caused by deficiencies of vitamin B12 and folate.
Fungi
Candida and Aspergillus species account for the majority of fungal infections of the small bowel. In comparison to Candida, Aspergillus hyphae are often seen in submucosal vessels spreading within the bowel wall in a radiating pattern.176 Other fungi that can involve the small bowel include Histoplasma, Mucor, Paracoccidioides, and Penicillium marneffei.
Of these, H. capsulatum is the most common endemic systemic mycosis in the United States; it occurs primarily, but not exclusively, in the central regions of the country. Gastrointestinal involvement occurs in 40% of patients with disseminated disease, and involvement of the small intestine is seen in 27%177; however, in contrast to other forms of disseminated histoplasmosis, fever and pulmonary involvement are unusual in gastrointestinal histoplasmosis.178 Terminal ileal involvement is commonly seen. Deep ulcerative lesions with undercut margins are characteristic of H. capsulatum involvement,178 but masses mimicking carcinoma, pseudopolyps, and lesions resembling xanthomas may also be seen.179 Histologically, yeast forms ranging from 2 to 4 µm in size lie within well-formed granulomas or macrophages scattered in the lamina propria in a pattern resembling Whipple disease or early enteritis caused by Mycobacterium avium-intracellulare (Fig. 9-22 ).
Figure 9-22.


A,Histoplasma capsulatum infection of the small intestine shows ulceration of the mucosa with non-necrotizing granulomas in the bowel wall. B, GMS stain reveals innumerable budding yeast forms.
Candida
Small intestinal candidal infections are rare in immunocompetent individuals with intact mucosal integrity, but they can be seen in up to 20% of autopsied patients with disseminated infection.180 All Candida species can infect immunocompromised patients, but there is a higher frequency of disseminated C. tropicalis.25 The gross appearance is variable; it includes mucosal flecks, sloughed membranes, ulcers of varying configuration, and nodular masses. Most invasive Candida infections are superficial176 and must be carefully differentiated from benign colonization. In colonization, Candida spp. may be identified embedded in the fibrinopurulent exudate that covers blind loops or in devitalized tissues without invasion of viable tissue. In immunocompromised or chronically debilitated patients, Candida can also invade deep into the intestinal wall and gain entry to the microvasculature, leading to ischemia and sepsis.
Viruses
Enteric Virus Infections
Numerous viruses, including rotavirus, enteric adenovirus, Norwalk virus, coronavirus, echovirus, enterovirus, calicivirus, and astrovirus,181., 182., 183. can cause gastroenteritis. Diagnosis is made based on viral culture, electron microscopy, ELISA of stool specimens, or genetic probes. Pathologists rarely obtain biopsies from patients with viral enteritis, but if they do, the bowel displays nonspecific findings such as reactive and degenerative changes of the epithelium and a mononuclear cell infiltrate in the lamina propria. Architectural changes of microvilli may also be seen.
Cytomegalovirus
CMV infection of the small intestine accounts for only 4% of all CMV infections, and CMV infection of the duodenum accounts for 22% of all CMV infections of the gastrointestinal tract.184 Immunosuppressed patients, including not only those with HIV infection but also those who undergo small bowel transplantation for short bowel syndrome, are prone to CMV infection. The latter group of patients show a high incidence of recurrence due to the heavy immunosuppression required to manage the graft.185 , 186 In this setting, PCR analysis of small-intestinal biopsy specimens may be a sensitive method for early detection of CMV and can be useful for preemptive therapy.187 The clinical manifestations of CMV infection include a wide spectrum of symptoms such as malaise, anorexia, fever, nausea, diarrhea, abdominal pain, ileus, gastrointestinal bleeding, and perforation. Severe complications such as hemorrhage and perforation are often preceded by vague symptoms for up to 2 weeks.188 , 189 The mortality associated with CMV enteritis is related to older age (>65 years) and delay in instituting therapy but not to the anatomic site of the infection.190
CMV enteritis tends to involve only a single region, rather than causing a panenteric infection.191 The pathologic changes range from few stromal or endothelial cells exhibiting CMV viral inclusions with no tissue reaction to frank ulceration and perforation. Almost any cell type may be infected, although CMV most frequently involves vascular endothelial or stromal cells (Fig. 9-23 ). The infected and swollen endothelial cells lead to luminal compromise, with fibrin thrombi formation that results in ischemic mucosal injury and, subsequently, ulceration.188
Figure 9-23.



Cytomegalovirus (CMV) infection superimposed on chronic ischemia of small intestine. The resection specimen of small intestine from a patient with HIV infection who presented with small-bowel obstruction reveals chronic enteritis with ulceration and mural fibrosis (A). Proliferating capillaries in the submucosa contain endothelial cells exhibiting atypical CMV cytopathic changes, i.e., cytomegaly with multiple small eosinophilic granules in the cytoplasm (arrowhead) (B) that react with CMV immunostain (C).
Human Immunodeficiency Virus–related Enteropathy
HIV enteropathy is a poorly defined clinical entity that represents pathogen-negative diarrhea in an HIV-infected individual. The possibility that it is related directly to local HIV infection is supported by the detection of HIV proteins and nuclear acids in various cell types of the intestine (i.e., epithelial cells, lymphocytes, and macrophages). Furthermore, combination antiretroviral therapy has led to improvement of gastrointestinal symptoms in these individuals.192
Two competing hypotheses have been advanced to explain the diarrheal disease of mucosal HIV infection. It has been suggested that HIV enteropathy is a pathophysiologic consequence of exposure to gp120, which arises from mononuclear cells of the lamina propria, and therefore is independent of epithelial HIV infection.193., 194., 195. Others have argued that the diarrhea is driven by cytokines (tumor necrosis factor and related moieties) released from infected lymphoid cells that can inhibit mucosal ion flux,196 , 197 resulting in malabsorption, diarrhea, and weight loss.198., 199., 200.
Vacuolated enterocytes may show conversion from columnar to cuboidal morphology, with cellular apoptosis, seen in a background of either villus and crypt atrophy or hyperplasia (Fig. 9-24 ). These epithelial changes are associated with mild mucosal inflammation, intraepithelial lymphocytosis, and dilated lacteals. The histologic changes are often mild and disproportionate to the symptoms.201 , 202
Figure 9-24.



Human immunodeficiency virus (HIV) enteropathy. A, Small-intestinal mucosa with partial villous blunting demonstrates apoptosis within the epithelium as well as in the lamina propria mononuclear cells. B, A region of apoptosis is seen (within circle). C, The lamina propria shows increased plasma cells.
Protozoa
Flagellates
Giardia intestinalis (Giardia lamblia) is the most prevalent human protozoan pathogen and the leading cause of waterborne diarrheal outbreaks in North America. G. intestinalis infection is associated with a broad spectrum of manifestations. Serious diarrhea illness with intestinal malabsorption and marked weight loss can be seen in young children and in previously unexposed adults, particularly travelers from low- to high-prevalence parts of the world. Infants and young children may suffer impairment of growth and development. However, in the vast majority of individuals world wide, the parasite is apparently carried without significant morbidity.203
The life cycle of Giardia includes two stages: cyst and trophozoite. The former is the infectious form; it is both relatively inert and environmentally resistant. After ingestion, excystation occurs in the duodenum as a result of exposure to gastric juice and pancreatic enzymes, yielding two trophozoites from each cyst.204 , 205 These trophozoites replicate in duodenal crypts and in the upper jejunum, reproducing asexually by binary fission.203 The cysts may be round or oval and measure 11 × 10 µm. They each have four nuclei, axonemes, and two median bodies. The trophozoites are 10 to 20 µm in length and 5 to 15 µm in width and have the shape of a teardrop when viewed from the dorsal or ventral aspect. They exhibit two identical nuclei and a ventral concave sucking disk with four pairs of flagella, two axonemes, and two median bodies.203 Disruption and distortion of the intestinal microvilli occurs at the site where the ventral disk interfaces with the microvillus membrane.206
The duodenal and/or jejunal biopsies from infected patients with normal absorption demonstrate preserved villous architecture with or without signs of epithelial damage, and intraepithelial lymphocytes are not increased (Fig. 9-25 ). Conversely, infected patients with proven intestinal malabsorption are likely to show mild to marked villous blunting, inflammatory expansion of the lamina propria, and increased intraepithelial lymphocytes.207., 208., 209., 210. A flattened mucosa is rarely seen. Even without apparent histologic abnormalities, trophozoites are usually found if at least two biopsy specimens are obtained from the duodenum.207 The organisms can be detected in gastric or ileal biopsies, and rarely in the colonic biopsies as well.208 Nodular lymphoid hyperplasia of the small intestine may also be seen.207 Patients whose biopsies lack lamina propria plasma cells usually have coexisting hypogammaglobulinemia.
Figure 9-25.


Giardia infection of duodenum in a patient who presented with acute onset of diarrhea after a camping trip. A, At low power, the duodenal mucosa is unremarkable and without significant inflammation or villous architectural distortion. B, High power reveals characteristic teardrop-shaped trophozoites between villi.
If normal or relatively preserved villous architecture is present, the differential diagnosis includes celiac sprue (Marsh I classification), other infectious agents (e.g., postviral enteritis, cryptosporidia, bacterial overgrowth), non-gluten food sensitivity (especially in children), use of nonsteroidal anti-inflammatory drugs (NSAIDs), autoimmune disorders, immunodeficiency, and inflammatory bowel disease, among others. If the mucosa is flat, the most important differential diagnosis is celiac sprue (Marsh III), given that both conditions are often associated with intestinal malabsorption. Other diseases to consider would include tropical sprue, autoimmune enteropathy, immunodeficiency, non-gluten food sensitivity, and infectious enteritis or protracted infection of the small intestine. However, with careful review of the small-intestinal biopsies, the offending trophozoites can usually be identified.
Coccidians
Cryptosporidium, Microsporidium, Isospora, and Cyclospora have all been identified in the small intestine of AIDS patients but are also important pathogens in otherwise healthy persons, including infants and children in developing countries (Table 9-6 ).211 , 212 Of these, microsporidia are single-celled, obligate intracellular parasites that have recently been reclassified from protozoa to fungi but will nevertheless be discussed in this section.213 Transmission is via the fecal-oral route, either by direct contact or through contaminated water or food.212
Table 9-6.
Comparison of Coccidians
| Coccidians | Morphology |
|---|---|
| Cryptosporidium parvum | 2-5 µm basophilic spherical bodies protruding from the apex of the enterocytes GMS negative |
| Cyclospora cayetanensis | 8-10 µm crescent or ovoid microorganisms normally located in enterocytes but can be present at the cell surface At some stages of infection, surrounded by a parasitophorous vacuole (EM) GMS negative |
| Isospora belli | 20-µm oval, blue enterocyte inclusions, both perinuclear and subnuclear Rarely present in the lamina propria or in macrophages At some stages of infection, surrounded by a parasitophorous vacuole (EM) |
| Microsporidia (Enterocytozoon bieneusi and Encephalitozoon intestinalis) | Difficult to detect in H&E-stained sections 2-3 µm apical inclusions in the enterocytes |
EM, electron microscopy; GMS, Grocott methenamine silver stain; H&E, hematoxylin and eosin stain.
In immunocompetent individuals, infection is usually self-limited and typically lasts for a few days but may persist for up to 4 weeks. Symptoms often consist of diarrhea, abdominal pain, and malaise. Nausea, vomiting, and fever may be reported. Conversely, immunocompromised patients are at risk for severe and chronic diarrhea that may be life-threatening. Weight loss and cramping abdominal pain are proportional to the severity of the diarrhea.
Other enteric opportunistic pathogens may infect profoundly immunocompromised patients.212 Patients with isosporiasis are likely to have peripheral eosinophilia. Endoscopic examination often shows normal intestinal mucosa or mild erythema, mucosal granularity, atrophy, and superficial erosions. Although all four coccidians primarily involve the mucosa of the small intestine, especially in the distal segment, the colonic mucosa and biliary tract can also be involved in the setting of heavy infection.212
Diagnosis is usually based on the examination of stool specimens. Less frequently, examination of duodenal/jejunal aspirates with special stains can establish the diagnosis. Evaluation of small bowel biopsy specimens by electron microscopy may be more sensitive than stool examination for the diagnosis of intestinal microsporidiosis (Figs. 9-26 and 9-27 ).214 , 215 With the development of sensitive diagnostic tests (e.g., ELISA), immunohistochemistry, and PCR,58 it is likely that low-intensity infections will be more frequently identified, with some probably of little clinical significance.212
Figure 9-26.

Enterocytozoon bieneusi infection of duodenum. A mucosal biopsy shows partial villous blunting, with the enterocytes infected with microsporidia spores (arrowhead) (toluidine blue stain).
Figure 9-27.

Microspora septata intestinale infection of duodenum. Spores are grouped in supranuclear vacuoles of enterocytes (arrowhead) (toluidine blue stain).
In all coccidial infections, the small-intestinal mucosa shows nonspecific findings, including normal intestinal mucosa in low-density infections or intraepithelial lymphocytosis, various degrees of villous atrophy, crypt hyperplasia, and mixed inflammation in the lamina propria if the organism burden is high.216 , 217 The diagnosis is based on organism morphology by light microscopy and/or ultrastructural examination of biopsy specimens. Microsporidia are difficult to detect in H&E-stained sections, but special stains such as GMS, PAS, modified acid-fast, modified trichrome, auramine, Warthin-Starry, and Brown-Brenn stains can aid greatly in the diagnosis (see Table 9-6).
Helminths
The conventional method used to diagnose gastrointestinal helminth infections is examination of stool for ova and parasites, but pathologists may at times encounter these organisms in endoscopic biopsies or in resection specimens. In this section, helminths that can affect the small intestine are briefly described.
Enterobius vermicularis (Pinworm)
Pinworms are one of the most common human parasites and tend to infest young children. They have a worldwide distribution, but they are more commonly seen in cold or temperate climates and in developed countries. The worms live and reproduce in the ileum, cecum, proximal colon, and appendix; however, pathologists are most likely to encounter them in colonic specimens, usually as an incidental finding in the appendix.
Ascaris lumbricoides
The distribution of ascariasis is worldwide, with the greatest frequency being in moist tropical climates. The mode of infection is fecal contamination of toys, soil, and fingers; contaminated raw vegetables; and drinking water. Usually. children are more vulnerable than adults to Ascaris infection. Patients may be asymptomatic, or they may complain of vague abdominal pain. However, massive infection with obstruction, perforation with peritonitis, appendicitis, and pancreatobiliary obstruction does occur.218., 219., 220.
Tissue damage may be seen primarily at the sites of attachment, but adult A. lumbricoides in the small intestine usually produces no diagnostic lesions.218., 219., 220. This nematode (round worm) is characterized by its large size, even in its larval form. The female worms reach lengths of greater than 30 cm; males are somewhat smaller. The helminth displays an annulate, multilayered cuticle with prominent hypodermis and conspicuous lateral cords. The female pseudocoelem includes paired genital tubes that contain innumerable ova which, when mature, exhibit prominent mamillations (Fig. 9-28 ). Even if the organism is no longer viable, it can be readily identified by virtue of its size.
Figure 9-28.


A,Ascaris lumbricoides with thick annulate cuticle and hypodermis. B, The mature ova of Ascaris exhibit prominent mamillations (arrowhead).
Ancylostomiasis (Hookworm)
The distribution of hookworm (Necator americanus and Ancylostoma duodenale) is worldwide, with particular prevalence in rural areas of the moist tropics where there is inadequate sanitation and people walk barefoot. The filariform larvae penetrate the skin of the feet or hands, enter venules, and are carried to the capillaries of the lung, where they break through the capillaries into alveolar sacs. They subsequently migrate through proximal airways to the gastrointestinal tract. Adult hookworms are creamy white, cylindrical nematodes with a large buccal capsule that includes teeth or cutting plates.219., 221., 222.
The patients are usually asymptomatic, but dyspepsia, nausea, and epigastric discomfort may occur. In addition, because the worms attach to the intestinal mucosa and withdraw blood from villous capillaries, anemia may ensue if the infestation is left untreated.
Mucosal damage is usually minor, but dense eosinophilic infiltrate extending into the submucosa or villous blunting may be seen. Biopsy specimens may occasionally reveal intestinal mucosa in the buccal cavity of the worm.219., 221., 222.
Strongyloides stercoralis
The distribution of S. stercoralis is worldwide, with the greatest prevalence in warm and wet regions. Adults, especially old, hospitalized, institutionalized, or immunocompromised individuals, are more prone than others to be infected by Strongyloides.
Filariform larvae penetrate the skin, enter the venous system, travel to the lung, and migrate up the proximal airways and down into the esophagus, eventually reaching the small intestine. Adult female worms parasitizing human small intestine lay eggs in the intestinal mucosa that hatch into rhabditiform larvae, which are shed in the stool. In an unfavorable environment, rhabditiform larvae transform into filariform larvae (parasitic phase). In the autoinfection cycle, rhabditiform larvae change into infective filiform larvae in the intestine or on the perianal skin and directly invade the host. This autoinfective capability leads to prolonged illness. Disseminated infection (i.e., migration of larvae to organs beyond the range of the autoinfective cycle) can occur in immunocompromised hosts and results in severe, life-threatening illness.218., 219., 223., 224., 225., 226., 227., 228., 229., 230. Systemic parasitic infection predisposes to gram-negative sepsis.
Adult female worms are 2 to 3 mm in length, with 1- to 2-µm thick cuticles and fine transverse striations. Eggs are 50 to 60 µm, oval, thin shelled, and embryonated when they exit the female. Rhabditiform larvae are 200 to 300 µm, and filariform larvae are 300 to 600 µm.218., 219., 223., 224., 225., 226., 227., 228., 229., 230.
Many patients are asymptomatic carriers, but abdominal pain, diarrhea, nausea, vomiting, anorexia, weight loss, and gastrointestinal bleeding, in any order or combination, have been reported. Ileus, small-bowel obstruction, and malnutrition also occur. Computed tomography scans occasionally reveal intra-abdominal lymphadenopathy. Gastrointestinal manifestations can be accompanied by pruritus, rash, eosinophilia, and pulmonary symptoms.218., 219., 223., 224., 225., 226., 227., 228., 229., 230.
Mucosal lesions may lead to esophagitis and gastritis in addition to duodenitis, jejunitis, ileitis, and colitis with pseudomembranous colitis. Mucosal ulceration is the most common finding in the small intestine, but it can occur at any level of the gastrointestinal tract. Histologically, the crypts are often distended by numerous larvae and adult worms (Fig. 9-29 ), but the organisms may be difficult to detect due to their patchy distribution. Other histologic features include villous blunting, ulcers and necrosis, edema, and a dense eosinophilic infiltrate of the lamina propria. Granulomas may also be seen.218., 219., 223., 224., 225., 226., 227., 228., 229., 230.
Figure 9-29.


Ileum of a patient infected with the adult Strongyloides stercoralis(A) and rhabditiform larvae (B) in crypts.
Capillaria philippinensis (Intestinal Capillariasis)
Although endemic in the Philippines and Thailand, cases of C. philippinensis have been reported in nonendemic areas. Transmission to humans is through ingestion of freshwater fish infected by larvae. The worms inhabit both the small and large intestine. At autopsy, as many as 200,000 worms can be recovered from a liter of intestinal contents. Autoinfection is attributed to the huge numbers of the organisms.219., 221., 231., 232.
The female worms range in size from 2.5 to 4.3 mm, and the male worms are slightly smaller. C. philippinensis eggs, 36 to 45 µm long, are barrel shaped with flattened bipolar plugs. C. philippinensis resembles Trichuris and Trichinella species but is distinguished from them by its characteristic ova. The symptoms of infection are nonspecific and include dull gastric pain or generalized abdominal pain, as well as watery and voluminous diarrhea with an increased amount of fat. Intractable diarrhea can lead to ascites and weight loss, followed by cachexia and death. The natural course of the disease is relatively rapid, and the period between onset of symptoms and death is as short as 2 to 3 months.219., 221., 231., 232.
Grossly, the small intestine is thickened, congested, and distended with fluid. An extremely large number of adult worms, larvae, and ova may be seen within the jejunum, the proximal portion of the ileum, and occasionally the duodenum. Worms are most commonly found in the crypts of the small intestine, but they may also invade the lamina propria. The intestinal villi tend to exhibit secondary changes such as villous atrophy and epithelial sloughing (Fig. 9-30 ).219., 221., 231., 232.
Figure 9-30.

Capillaria philippinensis. The involved ileum exhibits villous atrophy, epithelial sloughing, and a helminth in a crypt.
Trematodes
Schistosomiasis is the most common disease caused by trematodes worldwide. All Schistosoma species cause disease, and any level of the gastrointestinal tract may be affected. However, pathologists are most likely to encounter the organisms in colonic specimens.
Fasciolopsis buski (Intestinal Fluke)
Fasciolopsis buski infection is prevalent in countries of eastern Asia and the southwest Pacific, and the highest incidence is reported in eastern China. Transmission of the fluke to humans is via ingestion of aquatic plants, such as water chestnuts, containing infective metacercariae. These encyst in the duodenum, attach to the mucosa, and mature into adult worms in about 3 months.218., 233., 234., 235., 236., 237.
The adult is a flat, fleshy, ovate trematode that is 2 to 7.5 cm in length (Fig. 9-31 ). Eggs measure 130 to 140 µm in length and are ellipsoid, with a small operculum at one end.218., 233., 234., 235., 236., 237. The majority of infections remain asymptomatic; however, in cases of heavy infection, patients may develop diarrhea, often alternating with constipation, epigastric pain, nausea and vomiting, and hemorrhage, secondary to intestinal obstruction and mucosal injury. Also, the absorption of parasitic metabolites can cause generalized edema, which is most striking in the face. The duodenum and jejunum are most severely affected, with the large adult worms attaching to the mucosa and inducing an intense inflammation with possible ulceration and abscess formation. Leukocytosis and peripheral eosinophilia are also frequently associated with fasciolopsiasis.218., 233., 234., 235., 236., 237.
Figure 9-31.

Fasciolopsis buski (130 to 140 µm in length).
Cestodes
Adult Taenia saginata (beef tapeworm), Taenia solium (pork tapeworm), and Diphyllobothrium latum (fish tapeworm) are among the largest parasites that infect humans, and they occasionally cause gastrointestinal disease. About 40% of patients with Hymenolepis nana (dwarf tapeworm) infection have low vitamin B12 levels, because the tapeworm competes with the host for the vitamin.218., 238., 239.
Infectious Colitis
Although there is worldwide variation in the most common intestinal infectious agents, diseases that were once considered “tropical” are no longer diagnosed only in distant exotic places but may be encountered anywhere, as a result of international travel and migratory populations. In the West, breakdown in sanitary handling of food and contamination of poultry flocks, as well as the use of raw or partially cooked foods, have led to epidemics of infectious colitis.240
Infectious colitis manifests as an acute diarrheal disease frequently associated with hematochezia or microscopic evidence of blood loss. In North America, the diarrheas, commonly of bacterial etiology, are usually self-limited and are commonly referred to as “acute self-limited colitis.” However, in immunodeficient patients, presentations may be severe and a benign clinical outcome less certain.
Bacteria
Common Histologic Features of Bacterial (Invasive) Colitis
In response to infection, the colonic mucosa shows remarkable histologic variability. In practice, the dilemma is to distinguish between infectious colitis and the early manifestations of chronic inflammatory bowel disease. Early in the course of infectious colitis, edema of the lamina propria with clusters of neutrophils and ectatic capillaries are the dominant findings. Established crypt abscesses are rare. Commonly, the changes are patchy, and the overall mucosal architecture is preserved. Minimal degenerative changes, limited to the upper half of the mucosa, can be seen. These include mucin depletion and epithelial damage with flattened cytoplasm associated with cryptic dilatation. Concurrently, the inflammatory infiltrate of the lamina propria is mixed, characteristically with more neutrophils than lymphocytes and plasma cells. Microthrombi can plug dilated capillaries and can account for the focal hemorrhage of the lamina propria.
Later in the course of the infection, biopsies may show scattered neutrophils, inflammation with slightly decreased goblet cells, mucin depletion, and cellular degeneration, sometimes with vacuolization. Commonly, a mild increase in plasma cells is noted in the lamina propria, sometimes in association with lymphoid aggregates. However, a well-established dense basal lymphoplasmacytic infiltrate is uncommon. These changes habitually resolve in 2 to 3 weeks, or certainly within a trimester.241., 242., 243.
Histologic Features Associated with Bacterial Infection
Escherichia coli
E. coli is the most prevalent aerobic bacterium of the gut. Five variants are responsible for most common diarrheal illnesses (ETEC, EPEC, EIEC, EHEC, and EAEC species).244 The ETEC species include O157 : H7, which produces a verotoxin and results in a hemorrhagic colitis with features similar to those of ischemic colitis. The diarrheogenic E. coli (ETEC, EAggEC, and EIEC E. coli) account for more than 50% of traveler's diarrhea.245
In North America, E. coli O157 : H7 is the strain most commonly associated with the hemolytic and uremic syndrome. Its pathogenicity is attributable to two Shiga-like toxins (I and II). These toxins interact with a mucosal receptor in Peyer patches. Eventually, the absorbed toxins cause epithelial and endothelial damage of not only the colon but also the kidneys.246., 247., 248. Incubation takes about 4 days, and the illness lasts about 1 week. In many cases, the disease is self-limited, with minimal or even no diarrhea.
Those who develop a colitis may show various endoscopic appearances, ranging from normal mucosa to edema, erosion, and pseudomembranes. The histologic findings include overlapping features of both ischemic colitis and infectious colitis. Submucosal edema, hemorrhage, pseudomembranes, and withering crypts are seen, along with marked inflammatory infiltrate and cryptitis (Fig. 9-32 ).249 , 250
Figure 9-32.

Colitis associated with Escherichia coli O157 : H7 infection. The histology shows evidence of ischemic colitis with hyalinized stroma and withering crypts.
Aeromonas
Members of the bacterial genus Aeromonas produce a wide area of virulence factors and have been associated with cases of gastroenteritis, particularly in young children. Chronic symptoms also have been reported.251
Campylobacter
Campylobacter bacteria rank among the most common causes of infectious diarrhea. Most infections are self-limited cases of simple diarrhea, occasionally associated with systemic symptoms, but severe infections can occur. Domestic animals, particularly poultry, are reservoirs of infection, and the organism is primarily transmitted by the fecal-oral route. Infections peak in summer and early fall and generally result from ingestion of contaminated food or water.
Campylobacter jejuni, the most important species, produces typical infectious colitis that lasts from 1 to 7 days. The symptoms usually begin with a prodrome of fever, headache, and myalgias 12 to 24 hours before the onset of gastrointestinal symptoms. Colitis is reported in up to 80% of infections. Colonoscopic findings are nonspecific and range from segmental ulceration to diffuse colitis.252 Organisms may be seen in the lamina propria by ultrastructural analysis, and granulomatous changes with giant cells may also occur. On biopsy, a focal active colitis is observed.253 Rare cases produce changes mimicking ulcerative colitis.252 Complications include toxic megacolon and the development of Guillain-Barré syndrome.254 , 255
Shigella
The enteroinvasive Shigella bacteria cause mucosal changes resembling those of chronic inflammatory bowel disease.
Salmonella
Salmonella species are associated with a common form of infectious diarrhea. Classic typhoid fever due to S. typhi is primarily an ileal disease (see earlier discussion). However, nontyphoid salmonellosis may involve the colon as well.
At endoscopy, a wide range of nonspecific changes are seen. These include mild edema with petechial hemorrhage and, in severe cases, friability and ulceration. The histologic changes are indistinguishable from other types of bacterial diarrhea and some inflammatory bowel diseases, especially if the specimens were obtained early in the course of inflammatory bowel disease. Complications include the occasional development of toxic megacolon (Fig. 9-33 ).
Figure 9-33.

Colitis associated with Salmonella typhi infection. The lamina propria is moderately expanded by mixed lymphoplasmacytic infiltrate, as well as scattered neutrophils. Cryptitis is present as well. The morphologic features are not specific.
Clostridium difficile
C. difficile is a gram-positive bacillus that produces two principal toxins that play a role in pathogenesis of disease. Toxin A is an enterotoxin responsible for food accumulation in the gut and for damage to the enterocolonic mucosa; toxin B is a labile motility-altering cytotoxin that leads to food accumulation.
The spectrum of C. difficile colitis ranges from asymptomatic carriage to fulminant colitis. The presence of C. difficile infection has been steadily increasing in recent years, particularly among institutionalized patients, and it currently represents a major cause of hospital-acquired diarrhea. C. difficile infection is also prevalent in patients with inflammatory bowel disease (particularly ulcerative colitis) who are receiving maintenance immunomodulation therapy, and it is associated with exacerbation of the disease. It appears to play a minor role in sporadic diarrhea. It is well established that C. difficile infection follows exposures to antibiotics targeting gut anaerobes, and transmission occurs nosocomially from one host to another.
Toxigenic C. difficile is responsible for more than 90% of cases of pseudomembranous colitis and 30% to 40% of cases of antibiotic-associated colitis. The diarrhea usually begins within a few days after antibiotics are started. Some patients develop pseudomembranous colitis, whereas others suffer only mild diarrhea.
Pseudomembranous colitis due to C. difficile shows a spectrum of histologic changes, beginning with mild lesions that exhibit a luminal spray of mucus and neutrophils above a background mucosa with minimal inflammation. More advanced disease shows marked inflammatory erosion of the lamina propria covered by a fibrinopurulent cap and cystification of crypts. Finally, mucosal inflammation and erosion extends to form confluent pseudomembranes. In some patients, toxic megacolon ensues.256 In this setting, the finding of signet-ring cells should not be mistaken as indicating a carcinoma (Figure 9-34., Figure 9-35., Figure 9-36. ).257 The standard for diagnosis of C. difficile is a toxin test that is positive in more than 90% of patients with classic histologic changes of pseudomembranous colitis.
Figure 9-34.

Low-power view of specimen from a patient with Clostridium difficile–associated pseudomembranous colitis characterized by edema of the submucosa and destructive changes of the mucosa.
Figure 9-35.

At higher power, Clostridium difficile pseudomembranous colitis is characterized by sloughing off of superficial epithelial cells. The coating of fibrinopurulent material creates a pseudomembrane.
Figure 9-36.

Colitis in a patient with a positive toxin test for Clostridium difficile colitis but no evidence of pseudomembrane formation. Nonspecific degenerative changes of the surface epithelium, neutrophils, and mild expansion of the lamina propria are present.
Yersinia
Y. enterocolitica and Y. pseudotuberculosis are gram-negative aerobic coccobacilli. The latter species causes colitis that usually involves the terminal ileum and mesenteric lymph nodes (see earlier discussion). In Y. enterocolitica–associated acute colitis, the mucosa is erythematous and friable, with tiny superficial ulcerations. Granulomas are absent, but aggregates of histiocytes are frequently seen.
Mycobacterium tuberculosis
Tuberculosis of the colon, which is increasing in prevalence due to global travel, is essentially limited to the ileocecal region. Most patients have concomitant pulmonary tuberculosis. The tubercle bacillus can reach the gastrointestinal tract by several routes, including swallowed sputum, infected food, adjacent tissues, lymphatic spread, and via the bloodstream. Colonoscopy can be challenging, given the presence of ulceration and hypertrophic polypoid masses. Ulcerative, hyperplastic, and sclerotic variants may be seen. The differential diagnosis includes ileocecal Crohn disease and carcinoma.258
Biopsies reveal mucosal ulceration, granulation tissue, and microabscesses. Characteristic necrotizing granulomas are usually seen in the ulcer bed. The granulomas in tuberculosis are much larger than those seen in Crohn disease. They are confluent, and caseation is a common feature. AFB are demonstrated in 35% to 60% of cases. If M. tuberculosis is suspected, acid-fast staining of tissues and cultures is required to establish the diagnosis, and the recent development of PCR technology can increase the diagnostic yield.
Intestinal Spirochetosis
The prevalence of intestinal spirochetosis in rectal biopsies is between 2% and 7% in the West but between 11% and 34% in developing countries. Homosexual men and HIV-infected patients are reported to have the highest prevalence (up to 54%).
Whether the organism is of clinical significance or is a commensal bacterium has been debated. Colonoscopy reveals mucosal erosions and hyperemia. Histologically, the irregular luminal aspect of the surface epithelium seen on H&E-stained sections is emphasized by PAS or Warthin-Starry stains. Ultrastructural analysis also identifies the spirochetes. The disorder is most frequently seen in the right colon.259 The spirochetes or brachyspira, Brachyspira aalborgi and Brachyspira pilosicoli, are found between and parallel to the microvilli and do not penetrate the cytoplasm in most cases (Fig. 9-37 ). Mild inflammation may be seen in colonic biopsies. Improvement of symptoms and decrease in immunoglobulin E plasma cells within the lamina propria has been observed after treatment with metronidazole. Cases of severe colitis are rare but have been reported.260 , 261
Figure 9-37.

Intestinal spirochetosis. With Warthin-Starry stain, numerous tangled spirochetes are seen distributed along the apical surfaces of the mucosa (arrow).
Viruses
Many viruses, including rotavirus, enteric adenovirus, calicivirus, astrovirus, CMV, herpesvirus, and adenovirus can produce colitis. CMV, adenovirus, and HSV are considered here, as the only ones that are likely to be identified on endoscopic biopsies. A wide array of changes, from normal or edematous mucosa to ulcerative colitis, may be seen (Fig. 9-38 ).
Figure 9-38.

Amebiasis of the rectum. The colonic mucosa is moderately inflamed and shows a surface erosion with fibrinopurulent material.
Although CMV infection is usually subclinical, symptoms are common in immunologically suppressed patients, such as patients with AIDS, cancer patients undergoing chemotherapy, transplant recipients, and patients with inflammatory bowel disease.262 , 263 CMV colitis can be recognized by the presence of ulceration with or without colitis. The diagnosis of CMV infection depends on the identification of characteristic intranuclear inclusions. Typically, infected cells show endothelial, stromal, or epithelial nuclear and cytoplasmic enlargement with a single, dark red, amphophilic nuclear “bull's-eye” inclusion. However, it is not uncommon for infected cells to show indistinct, smudged, hematophilic nuclei. The cytoplasm of the infected cells can show either granular inclusion or a foamy appearance. The diagnosis can be rendered difficult by granulation tissue arising secondary to the ulceration and the reactive stromal cells. Immunohistochemistry allows a diagnosis to be made in atypical cases.264
HSV is a common cause of proctitis in male homosexual patients, in AIDS patients, and in other immunosuppressed individuals. The ulcerations commonly demonstrate peripheral giant cells. Nonspecific cases of severe acute colitis with widespread ulceration have been reported.265
Adenovirus is believed to be a common cause of diarrhea in children and patients with HIV infection. Infected vacuolated epithelial cells are found close to the mucosal surface, with amphophilic nuclei that can be either enlarged or crescent-shaped, and the presence of virus can be confirmed by immunocytochemistry. Small intranuclear inclusions are also visible.
Protozoa
The diagnostic identification of protozoa is best done by examination of fresh stool. There is no characteristic histologic pattern on biopsy, and the organisms are usually overlooked on sections unless a careful inspection is made.
Amebiasis
Entamoeba histolytica is found in all climates. Infection is acquired via fecal contamination and ingestion of cysts. In the West, a history of foreign travel to areas of poor sanitation is common, although sexually transmitted cases have been recognized. Infected individuals may present with various symptoms, including toxic megacolon. The range of symptoms is explained in part by the existence of 22 different zymodemes.
Early in infection, edema and nonspecific inflammation with clusters of neutrophils are seen in the lamina propria and surface epithelium. The amebas may be present on the surface, usually in the overlying inflammatory exudate. With time, a large, flask-shaped ulceration may develop. The epithelium shows goblet cell depletion and microulceration with organisms in the exudate overlying the denuded lamina propria (Fig. 9-38). Although there are numerous neutrophils in the lamina propria, crypt abscesses are not conspicuous, and tissue eosinophilia is not a feature.
Deep necrosis with ulceration extending to the submucosa can be seen in severe cases. The mucosa is replaced by a thick, amorphous inflammatory fibrinoid material with abundant organisms and scattered inflammatory cells. The infective trophozoites are at times substantially larger (10-60 µm) than macrophages, display foamy amphophilic cytoplasm with ingested erythrocytes, and sport a punctate central karyosome (Fig. 9-39). The PAS stain aids in recognition of the amebas but obscures the presence of the diagnostic karyosome and ingested erythrocytes. Of note, antidiarrheal preparations can destroy the protozoa and should be avoided before biopsy. Current diagnostic tools include antigen detection in stool and PCR (Fig. 9-39 ; see Fig. 9-38).266
Figure 9-39.

Amebiasis of the rectum. Higher magnification shows numerous Entamoeba histolytica distributed along the surface epithelium.
Coccidia
Coccidia is a collective name for the suborder that includes other human pathogens such as Isospora, Sarcocystis, and Toxoplasma. The diagnosis of these intracellular pathogens is difficult to evaluate on colorectal biopsy. Cryptosporidium parvum can be seen in immunocompromised as well as normal subjects, but with a markedly different clinical presentation. The former may present with severe diarrhea, sometimes with toxic megacolon. In the setting of AIDS, several other microorganisms are frequently associated. In immunocompetent individuals, C. parvum infection usually manifests as a self-limited, flu-like gastroenteritis; it has also been noted as a cause of traveler's diarrhea.
On biopsy, a nonspecific inflammatory infiltrate and rare ulceration are seen. Cryptosporidia are observed as clusters of tiny hematoxylin dots on the epithelial surface or within the crypt. PAS, silver, or Giemsa stain is also helpful in highlighting the organisms (Fig. 9-40 ).
Figure 9-40.

Cryptosporidia parvum infection in an immunosuppressed patient. The organisms coat the surface epithelium and should not be mistaken for extruded mucin globules.
Other Protozoan Infections
Giardiasis is more commonly recognized in the small bowel, but rare cases of colonic infection have been documented.
Balantidium coli is a ciliated protozoan. Patients are infected through contact with pigs or rats under conditions of poor personal hygiene. After ingestion of cysts, the trophozoite resides predominantly in the colon. The mucosal lesions are similar to those of amebiasis. Symptoms may include acute diarrhea, fulminant colitis, and perforation. Asymptomatic carriers are recognized.267
Helminths
Three classes of helminths can lead to human infection: trematodes (flukes), nematodes (roundworms), and cestodes (tapeworms). Only schistosomiasis leads to colorectal infestation.
Schistosoma mansoni and Schistosoma japonicum are the two common trematode worms affecting the colon. The adults reside in the major mesenteric veins, and the disease is caused primarily by an inflammatory reaction to the eggs. The rectal mucosa and submucosa are a good location for identification of S. mansoni eggs, whereas those of S. japonicum are generally seen in the right colon. The presence of miracidial nuclei indicates that organisms are viable. The ova of S. mansoni are characterized by subterminal spines, whereas the eggs of S. japonicum have ill-defined subterminal knobs. The eggs are usually surrounded by inflammatory infiltrate in which eosinophils predominate. A granulomatous reaction may develop. In some cases, the eggs are surrounded by an eosinophilic zone of fibrin material, representing an antigen-antibody complex. With time, fibrosis develops around the calcified ova. The lateral spine of S. mansoni and the cortical shell stain variably with modified AFB stain; unlike paragonimiasis, the ova are nonrefractile. In countries with endemic infection, the entire colon may become fibrotic, studded with polyps and ulcers. There is an increased incidence of adenocarcinoma in these patients (Figs. 9-41 and 9-42 ).268 , 269
Figure 9-41.


A, The tuberculated tegument (arrowhead) of an adult male Schistosoma mansoni lodged within a mesenteric vein (arrow). B, Low-power magnification demonstrates degenerating ova within the rectal mucosa.
Figure 9-42.


A, Colonic schistosomiasis characterized by an ill-formed submucosal granuloma. The inset demonstrates the terminal spine with surrounding ill-formed granulomatous reaction. B, A Fite stain highlights the cortex and lateral spine of Schistosoma mansoni.
Strongyloidiasis, trichuriasis, and oxyuriasis are common nematode infestations of the lower gastrointestinal tract. Although S. stercoralis is usually restricted to the small intestine, migratory larvae can implant in the colonic mucosa, leading to autoinfection, particularly in the setting of massive infestation. The parasites are found in crypts and superficial mucosae, usually surrounded by transmural eosinophilic inflammation.270
Trichuris trichiura (whipworm) preferentially infests the cecum. The body structure of the worm is unique. The anterior three fifths of the worm is threadlike and embeds into the mucosa, whereas the remainder of the organism floats within the lumen. The esophagus shows a characteristic stichosome, and the anterior wall shows characteristic bacillary bands. The posterior part of the worm exhibits the reproductive organs (Fig. 9-43 ). Trichuris causes chronic dysentery. On biopsy, the worm is usually surrounded by an intense focal eosinophilic infiltrate.
Figure 9-43.

Trichuris trichiura. The anterior portion of the nematode with stichosome (arrow) and bacillary band (arrowhead) is embedded in the superficial mucosa, while the posterior two thirds of the helminth containing the sexual organs projects into the bowel lumen (broad arrow).
Oxyuriasis, or Enterobius vermicularis, is the most prevalent parasitic helminth recognized in the West. The adult pinworm attaches to the cecal mucosa, and the worm is commonly observed in the lumen of the appendix. Symptoms result from the nocturnal migration of the adult female; she lays eggs on the perianal skin, causing intense pruritus. Diagnosis is classically established by adhering the deposited ova to cellophane tape and examining them under the microscope. Refractile ova are characteristically flattened on one side. The helminth is small, shows a muscular wall, and exhibits prominent lateral alae projecting from the cuticle throughout its length. The central oviducts contain the characteristic flattened eggs. The surrounding mucosa is generally inflamed, and tissue eosinophilia may be present (Fig. 9-44 ). Inflammatory reaction may produce a presenting polyp or even a mass, sometimes mistaken for a carcinoma.271 Aberrant migration can lead to similar lesions in the vagina and bladder.
Figure 9-44.


A,Enterobius vermicularis within the appendiceal lumen. B, The helminth shows prominent lateral alae (arrowhead), platymyarian muscle (arrow), and flattened refractile ova (asterisk).
Fungi
Fungal infections of the large bowel are rare. They are commonly opportunistic infections of immunocompromised hosts, although in some regions, histoplasmosis, coccidioidomycosis, and paracoccidioidomycosis are endemic. Histoplasma is the organism most likely to involve the gut, and the diagnosis depends on identification of the fungus on biopsy. This is best achieved with silver stains. The dimorphic fungus is most often represented in its yeast form, but mycelial growth may be present. The mass mimics carcinoma, from which it must be distinguished.
Sexually Transmitted Diseases
Proctitis is common in homosexual men and is frequently related to infection by Neisseria gonorrhoeae, Treponema pallidum, chlamydia, or HSV.272 The symptoms of gonorrhea, caused by the gram-negative diplococcus N. gonorrhoeae, vary from pruritus to severe proctitis and diarrhea. Biopsies frequently are not diagnostic and show either normal mucosa or nonspecific inflammatory change. Fewer than 5% of patients show infectious proctitis.273
Secondary syphilis can manifest as proctitis. The changes include marked inflammation, in which small granulomas with giant cells are usually prominent.272 Chlamydia trachomatis is an obligate intracellular bacterium that ranks among the most common causes of sexually transmitted clinical proctitis.272
Lymphogranuloma Venereum
In acute cases of lymphogranuloma venereum, the mucosa shows a mixed inflammatory infiltrate. Giant cell granuloma can be seen in association with disrupted crypts. A common differential diagnosis is ulcerative colitis, and the diagnosis is confirmed by immunofluorescent methods. The inflammatory infiltrate may be transmural or may give a pattern of follicular proctitis. Strictures and adenocarcinoma have been reported in chronic infection.
REFERENCES
- 1.McDonald GB, Sharma P, Hackman RC. Esophageal infections in immunosuppressed patients after marrow transplantation. Gastroenterology. 1985;88(5 Pt 1):1111–1117. doi: 10.1016/s0016-5085(85)80068-8. [DOI] [PubMed] [Google Scholar]
- 2.Walsh TJ, Belitsos NJ, Hamilton SR. Bacterial esophagitis in immunocompromised patients. Arch Intern Med. 1986;146:1345–1348. [PubMed] [Google Scholar]
- 3.Baehr PH, McDonald GB. Esophageal infections: Risk factors, presentation, diagnosis, and treatment. Gastroenterology. 1994;106:509–532. doi: 10.1016/0016-5085(94)90613-0. [DOI] [PubMed] [Google Scholar]
- 4.Ezzell JH, Jr, Bremer J, Adamec TA. Bacterial esophagitis: An often forgotten cause of odynophagia. Am J Gastroenterol. 1990;85:296–298. [PubMed] [Google Scholar]
- 5.Fenoglio-Preiser CM. vol 2. Mosby; St. Louis: 1989. (Advances in Pathology). [Google Scholar]
- 6.Gupta NM, Goenka MK, Vaiphei K. Isolated esophageal tuberculosis. Indian J Gastroenterol. 1995;14:25–26. [PubMed] [Google Scholar]
- 7.Lockard LB. Esophageal tuberculosis: A critical review. Laryngoscope. 1913;23:561–584. [Google Scholar]
- 8.Wort SJ, Puleston JM, Hill PD, Holdstock GE. Primary tuberculosis of the oesophagus. Lancet. 1997;349(9058):1072. doi: 10.1016/s0140-6736(05)62295-7. [DOI] [PubMed] [Google Scholar]
- 9.Mokoena T, Shama DM, Ngakane H, Bryer JV. Oesophageal tuberculosis: A review of eleven cases. Postgrad Med J. 1992;68(796):110–115. doi: 10.1136/pgmj.68.796.110. [DOI] [PMC free article] [PubMed] [Google Scholar]
- 10.Nagi B, Lal A, Kochhar R. Imaging of esophageal tuberculosis: A review of 23 cases. Acta Radiol. 2003;44:329–333. doi: 10.1080/j.1600-0455.2003.00069.x. [DOI] [PubMed] [Google Scholar]
- 11.Williford ME, Thompson WM, Hamilton JD, Postlethwait RW. Esophageal tuberculosis: Findings on barium swallow and computed tomography. Gastrointest Radiol. 1983;8:119–122. doi: 10.1007/BF01948102. [DOI] [PubMed] [Google Scholar]
- 12.Iwamoto I, Tomita Y, Takasaki M. Esophagoaortic fistula caused by esophageal tuberculosis: Report of a case. Surg Today. 1995;25:381–384. doi: 10.1007/BF00311266. [DOI] [PubMed] [Google Scholar]
- 13.Newman RM, Fleshner PR, Lajam FE, Kim U. Esophageal tuberculosis: A rare presentation with hematemesis. Am J Gastroenterol. 1991;86:751–755. [PubMed] [Google Scholar]
- 14.Gupta SP, Arora A, Bhargava DK. An unusual presentation of oesophageal tuberculosis. Tuber Lung Dis. 1992;73:174–176. doi: 10.1016/0962-8479(92)90153-b. [DOI] [PubMed] [Google Scholar]
- 15.Prakash K, Kuruvilla K, Lekha V. Primary tuberculous stricture of the oesophagus mimicking carcinoma. Trop Gastroenterol. 2001;22:143–144. [PubMed] [Google Scholar]
- 16.Sinha SN, Tesar P, Seta W, Sengupta SK. Primary oesophageal tuberculosis. Br J Clin Pract. 1988;42:391–394. [PubMed] [Google Scholar]
- 17.Damtew B, Frengley D, Wolinsky E, Spagnuolo PJ. Esophageal tuberculosis: Mimicry of gastrointestinal malignancy. Rev Infect Dis. 1987;9:140–146. doi: 10.1093/clinids/9.1.140. [DOI] [PubMed] [Google Scholar]
- 18.Clouse RE, Abramson BK, Todorczuk JR. Achalasia in the elderly: Effects of aging on clinical presentation and outcome. Dig Dis Sci. 1991;36:225–228. doi: 10.1007/BF01300761. [DOI] [PubMed] [Google Scholar]
- 19.De Wit D, Steyn L, Shoemaker S, Sogin M. Direct detection of Mycobacterium tuberculosis in clinical specimens by DNA amplification. J Clin Microbiol. 1990;28:2437–2441. doi: 10.1128/jcm.28.11.2437-2441.1990. [DOI] [PMC free article] [PubMed] [Google Scholar]
- 20.Eisenach KD, Sifford MD, Cave MD. Detection of Mycobacterium tuberculosis in sputum samples using a polymerase chain reaction. Am Rev Respir Dis. 1991;144:1160–1163. doi: 10.1164/ajrccm/144.5.1160. [DOI] [PubMed] [Google Scholar]
- 21.Kim KM, Lee A, Choi KY. Intestinal tuberculosis: Clinicopathologic analysis and diagnosis by endoscopic biopsy. Am J Gastroenterol. 1998;93:606–609. doi: 10.1111/j.1572-0241.1998.173_b.x. [DOI] [PubMed] [Google Scholar]
- 22.Perosio PM, Frank TS. Detection and species identification of mycobacteria in paraffin sections of lung biopsy specimens by the polymerase chain reaction. Am J Clin Pathol. 1993;100:643–647. doi: 10.1093/ajcp/100.6.643. [DOI] [PubMed] [Google Scholar]
- 23.Centers for Disease Control and Prevention Revision of the case definition of acquired immunodeficiency syndrome for national reporting—United States. Ann Intern Med. 1985;103:402–403. [PubMed] [Google Scholar]
- 24.Thom K, Forrest G. Gastrointestinal infections in immunocompromised hosts. Curr Opin Gastroenterol. 2006;22:18–23. doi: 10.1097/01.mog.0000196149.29077.0d. [DOI] [PubMed] [Google Scholar]
- 25.Walsh TJ, Merz WG. Pathologic features in the human alimentary tract associated with invasiveness of Candida tropicalis. Am J Clin Pathol. 1986;85:498–502. doi: 10.1093/ajcp/85.4.498. [DOI] [PubMed] [Google Scholar]
- 26.Geagea A, Cellier C. Scope of drug-induced, infectious and allergic esophageal injury. Curr Opin Gastroenterol. 2008;24:496–501. doi: 10.1097/MOG.0b013e328304de94. [DOI] [PubMed] [Google Scholar]
- 27.Kirkpatrick CH. Chronic mucocutaneous candidiasis. J Am Acad Dermatol. 1994;31(3 Pt 2):S14–S17. doi: 10.1016/s0190-9622(08)81260-1. [DOI] [PubMed] [Google Scholar]
- 28.Abildgaard N, Haugaard L, Bendix K. Nonfatal total expulsion of the distal oesophagus due to invasive candida oesophagitis. Scand J Infect Dis. 1993;25:153–156. [PubMed] [Google Scholar]
- 29.Jacobs DH, Macher AM, Handler R. Esophageal cryptococcosis in a patient with the hyperimmunoglobulin E-recurrent infection (Job's) syndrome. Gastroenterology. 1984;87:201–203. [PubMed] [Google Scholar]
- 30.Jenkins DW, Fisk DE, Byrd RB. Mediastinal histoplasmosis with esophageal abscess: Two case reports. Gastroenterology. 1976;70:109–111. [PubMed] [Google Scholar]
- 31.Miller DP, Everett ED. Gastrointestinal histoplasmosis. J Clin Gastroenterol. 1979;1:233–236. doi: 10.1097/00004836-197909000-00008. [DOI] [PubMed] [Google Scholar]
- 32.Mineur P, Ferrant A, Wallon J. Bronchoesophageal fistula caused by pulmonary aspergillosis. Eur J Respir Dis. 1985;66:360–366. [PubMed] [Google Scholar]
- 33.Bibbo M. WB Saunders; Philadelphia: 1997. Comprehensive Cytopathology. [Google Scholar]
- 34.Dail DH, Hammer SP. Springer-Verlag; New York: 1994. Pulmonary Pathology. [Google Scholar]
- 35.DeMay RM. ASCP Press; Chicago: 1996. The Art and Science of Cytopathology. [Google Scholar]
- 36.Tucker LE, Aquino T, Sasser W. Mid-esophageal traction diverticulum: Rare cause of massive upper gastrointestinal bleeding. Mo Med. 1994;91:140–142. [PubMed] [Google Scholar]
- 37.Nash G, Ross JS. Herpetic esophagitis: A common cause of esophageal ulceration. Hum Pathol. 1974;5:339–345. doi: 10.1016/s0046-8177(74)80116-4. [DOI] [PubMed] [Google Scholar]
- 38.Wandl-Hainberger I, Pichler W, Lechner G. [Ulcerative herpes simplex virus II esophagitis] Rofo. 1988;148:215–216. doi: 10.1055/s-2008-1048182. [DOI] [PubMed] [Google Scholar]
- 39.Whitley RJ. Neonatal herpes simplex virus infections. J Med Virol. 1993;Suppl 1:13–21. doi: 10.1002/jmv.1890410505. [DOI] [PubMed] [Google Scholar]
- 40.Rattner HM, Cooper DJ, Zaman MB. Severe bleeding from herpes esophagitis. Am J Gastroenterol. 1985;80:523–525. [PubMed] [Google Scholar]
- 41.Byard RW, Champion MC, Orizaga M. Variability in the clinical presentation and endoscopic findings of herpetic esophagitis. Endoscopy. 1987;19:153–155. doi: 10.1055/s-2007-1018267. [DOI] [PubMed] [Google Scholar]
- 42.Jenkins D, Wicks AC. Herpes simplex esophagitis in a renal transplant patient: The need for antiviral therapy. Am J Gastroenterol. 1988;83:331–332. [PubMed] [Google Scholar]
- 43.Shortsleeve MJ, Levine MS. Herpes esophagitis in otherwise healthy patients: Clinical and radiographic findings. Radiology. 1992;182:859–861. doi: 10.1148/radiology.182.3.1535908. [DOI] [PubMed] [Google Scholar]
- 44.Watts SJ, Alexander LC, Fawcett K. Herpes simplex esophagitis in a renal transplant patient treated with cyclosporine A: A case report. Am J Gastroenterol. 1986;81:185–188. [PubMed] [Google Scholar]
- 45.Greenson JK, Beschorner WE, Boitnott JK, Yardley JH. Prominent mononuclear cell infiltrate is characteristic of herpes esophagitis. Hum Pathol. 1991;22:541–549. doi: 10.1016/0046-8177(91)90230-m. [DOI] [PubMed] [Google Scholar]
- 46.Cardillo MR, Forte F. Brush cytology in the diagnosis of herpetic esophagitis: A case report. Endoscopy. 1988;20:156–157. doi: 10.1055/s-2007-1018164. [DOI] [PubMed] [Google Scholar]
- 47.McBane RD, Gross JB., Jr Herpes esophagitis: Clinical syndrome, endoscopic appearance, and diagnosis in 23 patients. Gastrointest Endosc. 1991;37:600–603. doi: 10.1016/s0016-5107(91)70862-6. [DOI] [PubMed] [Google Scholar]
- 48.Singh SP, Odze RD. Multinucleated epithelial giant cell changes in esophagitis: A clinicopathologic study of 14 cases. Am J Surg Pathol. 1998;22:93–99. doi: 10.1097/00000478-199801000-00012. [DOI] [PubMed] [Google Scholar]
- 49.Reed EC, Wolford JL, Kopecky KJ. Ganciclovir for the treatment of cytomegalovirus gastroenteritis in bone marrow transplant patients: A randomized, placebo-controlled trial. Ann Intern Med. 1990;112:505–510. doi: 10.7326/0003-4819-112-7-505. [DOI] [PubMed] [Google Scholar]
- 50.Weber JN, Thom S, Barrison I. Cytomegalovirus colitis and oesophageal ulceration in the context of AIDS: Clinical manifestations and preliminary report of treatment with Foscarnet (phosphonoformate) Gut. 1987;28:482–487. doi: 10.1136/gut.28.4.482. [DOI] [PMC free article] [PubMed] [Google Scholar]
- 51.Levine MS, Loercher G, Katzka DA. Giant, human immunodeficiency virus-related ulcers in the esophagus. Radiology. 1991;180:323–326. doi: 10.1148/radiology.180.2.2068293. [DOI] [PubMed] [Google Scholar]
- 52.Connolly GM, Hawkins D, Harcourt-Webster JN. Oesophageal symptoms, their causes, treatment, and prognosis in patients with the acquired immunodeficiency syndrome. Gut. 1989;30:1033–1039. doi: 10.1136/gut.30.8.1033. [DOI] [PMC free article] [PubMed] [Google Scholar]
- 53.Hirsch MS. Herpes group virus infections in the compromised host. In: Rubun RH, Young LS, editors. Clinical Approach to Infection in the Compromised Host. Plenum; New York: 1988. pp. 347–366. [Google Scholar]
- 54.Meigh RE, Getty B, Bone JM, Hart CA. Varicella in an immunocompromised patient: An electron microscopic study. NIPH Ann. 1989;12:3–12. [PubMed] [Google Scholar]
- 55.Gelb JD. Varicella-zoster virus. In: Field BN, Knipe DM, editors. Virology. 2nd ed. Raven Press; New York: 1990. pp. 2011–2054. [Google Scholar]
- 56.Hording M, Hording U, Daugaard S. Human papilloma virus type 11 in a fatal case of esophageal and bronchial papillomatosis. Scand J Infect Dis. 1989;21:229–231. doi: 10.3109/00365548909039974. [DOI] [PubMed] [Google Scholar]
- 57.Janson JA, Baillie J, Pollock M. Endoscopic removal of esophageal condylomata acuminatum containing human papilloma virus. Gastrointest Endosc. 1991;37:367–370. doi: 10.1016/s0016-5107(91)70735-9. [DOI] [PubMed] [Google Scholar]
- 58.Schechter M, Pannain VL, de Oliveira AV. Papovavirus-associated esophageal ulceration in a patient with AIDS. AIDS. 1991;5:238. doi: 10.1097/00002030-199102000-00026. [DOI] [PubMed] [Google Scholar]
- 59.Winkler B, Capo V, Reumann W. Human papillomavirus infection of the esophagus: A clinicopathologic study with demonstration of papillomavirus antigen by the immunoperoxidase technique. Cancer. 1985;55:149–155. doi: 10.1002/1097-0142(19850101)55:1<149::aid-cncr2820550123>3.0.co;2-9. [DOI] [PubMed] [Google Scholar]
- 60.Silverstein FE, Tytgat GNJ. 2nd ed. Gower; New York: 1991. Atlas of Gastrointestinal Endoscopy. [Google Scholar]
- 61.Tilbe KS, Lloyd DA. A case of viral esophagitis. J Clin Gastroenterol. 1986;8:494–495. doi: 10.1097/00004836-198608000-00025. [DOI] [PubMed] [Google Scholar]
- 62.Greenspan JS, Greenspan D, Lennette ET. Replication of Epstein-Barr virus within the epithelial cells of oral “hairy” leukoplakia, an AIDS-associated lesion. N Engl J Med. 1985;313:1564–1571. doi: 10.1056/NEJM198512193132502. [DOI] [PubMed] [Google Scholar]
- 63.Kitchen VS, Helbert M, Francis ND. Epstein-Barr virus associated oesophageal ulcers in AIDS. Gut. 1990;31:1223–1225. doi: 10.1136/gut.31.11.1223. [DOI] [PMC free article] [PubMed] [Google Scholar]
- 64.Wilcox CM, Schwartz DA, Clark WS. Esophageal ulceration in human immunodeficiency virus infection: Causes, response to therapy, and long-term outcome. Ann Intern Med. 1995;123:143–149. doi: 10.7326/0003-4819-123-2-199507150-00010. [DOI] [PubMed] [Google Scholar]
- 65.Akhtar M, Ali MA, Sackey K. Fine-needle aspiration biopsy diagnosis of endodermal sinus tumor: Histologic and ultrastructural correlations. Diagn Cytopathol. 1990;6:184–192. doi: 10.1002/dc.2840060308. [DOI] [PubMed] [Google Scholar]
- 66.Rabeneck L, Popovic M, Gartner S. Acute HIV infection presenting with painful swallowing and esophageal ulcers. JAMA. 1990;263:2318–2322. [PubMed] [Google Scholar]
- 67.Bonacini M, Young T, Laine L. Histopathology of human immunodeficiency virus-associated esophageal disease. Am J Gastroenterol. 1993;88:549–551. [PubMed] [Google Scholar]
- 68.Ehrenpreis ED, Bober DI. Idiopathic ulcerations of the oesophagus in HIV-infected patients: A review. Int J STD AIDS. 1996;7:77–81. doi: 10.1258/0956462961917401. [DOI] [PubMed] [Google Scholar]
- 69.Kotler DP, Wilson CS, Haroutiounian G, Fox CH. Detection of human immunodeficiency virus-1 by 35S-RNA in situ hybridization in solitary esophageal ulcers in two patients with the acquired immune deficiency syndrome. Am J Gastroenterol. 1989;84:313–317. [PubMed] [Google Scholar]
- 70.Jalfon IM, Sitton JE, Hammer RA. HIV-1 gp41 antigen demonstration in esophageal ulcers with acquired immunodeficiency syndrome. J Clin Gastroenterol. 1991;13:644–648. doi: 10.1097/00004836-199112000-00007. [DOI] [PubMed] [Google Scholar]
- 71.Kotler DP, Reka S, Orenstein JM, Fox CH. Chronic idiopathic esophageal ulceration in the acquired immunodeficiency syndrome: Characterization and treatment with corticosteroids. J Clin Gastroenterol. 1992;15:284–290. doi: 10.1097/00004836-199212000-00004. [DOI] [PubMed] [Google Scholar]
- 72.Gill MJ, Sutherland LR, Church DL. Gastrointestinal tissue cultures for HIV in HIV-infected/AIDS patients. The University of Calgary Gastrointestinal/HIV Study Group. AIDS. 1992;6:553–556. doi: 10.1097/00002030-199206000-00005. [DOI] [PubMed] [Google Scholar]
- 73.Bach MC, Valenti AJ, Howell DA, Smith TJ. Odynophagia from aphthous ulcers of the pharynx and esophagus in the acquired immunodeficiency syndrome (AIDS) Ann Intern Med. 1988;109:338–339. doi: 10.7326/0003-4819-109-4-338. [DOI] [PubMed] [Google Scholar]
- 74.Wilcox CM, Schwartz DA. A pilot study of oral corticosteroid therapy for idiopathic esophageal ulcerations associated with human immunodeficiency virus infection. Am J Med. 1992;93:131–134. doi: 10.1016/0002-9343(92)90041-9. [DOI] [PubMed] [Google Scholar]
- 75.Bonnet F, Neau D, Viallard JF. Clinical and laboratory findings of cytomegalovirus infection in 115 hospitalized non-immunocompromised adults. Ann Med Intern. 2001;152:227–235. [PubMed] [Google Scholar]
- 76.Hinnant KL, Rotterdam HZ, Bell ET, Tapper ML. Cytomegalovirus infection of the alimentary tract: A clinicopathological correlation. Am J Gastroenterol. 1986;81:944–950. [PubMed] [Google Scholar]
- 77.Emory TS, Carpenter HA, Gostout CJ, Sobin LH. Armed Forces Institute of Pathology; Washington, DC: 2000. Atlas of Gastrointestinal Endoscopy and Endoscopic Biopsies. [Google Scholar]
- 78.Xiao SY, Hart J. Marked gastric foveolar hyperplasia associated with active cytomegalovirus infection. Am J Gastroenterol. 2001;96:223–226. doi: 10.1111/j.1572-0241.2001.03480.x. [DOI] [PubMed] [Google Scholar]
- 79.Andrade JS, Bambirra EA, Lima GF. Gastric cytomegalic inclusion bodies diagnosed by histologic examination of endoscopic biopsies in patients with gastric ulcer. Am J Clin Pathol. 1983;79:493–496. doi: 10.1093/ajcp/79.4.493. [DOI] [PubMed] [Google Scholar]
- 80.Goldman H, Hayek J, Federman M. 1st ed. Churchill Livingstone; New York: 1996. Gastrointestinal Mucosal Biopsy. [Google Scholar]
- 81.Rivera-Vaquerizo PA, Gomez-Garrido J, Vicente-Gutierrez M. Varicella zoster gastritis 3 years after bone marrow transplantation for treatment of acute leukemia. Gastrointest Endosc. 2001;53:809–810. doi: 10.1067/mge.2001.114421. [DOI] [PubMed] [Google Scholar]
- 82.Vieth M, Dirshmid K, Oehler U. Acute measles gastric infection. Am J Surg Pathol. 2001;25:259–262. doi: 10.1097/00000478-200102000-00015. [DOI] [PubMed] [Google Scholar]
- 83.O’Toole PA, Morris JA. Acute phlegmonous gastritis. Postgrad Med J. 1988;64:315–316. doi: 10.1136/pgmj.64.750.315. [DOI] [PMC free article] [PubMed] [Google Scholar]
- 84.Bron BA, Deyhle P, Pelloni S. Phlegmonous gastritis diagnosed by endoscopic snare biopsy. Am J Dig Dis. 1977;22:729–733. doi: 10.1007/BF01078356. [DOI] [PubMed] [Google Scholar]
- 85.Mittleman RE, Suarez RV. Phlegmonous gastritis associated with the acquired immunodeficiency syndrome/pre-acquired immunodeficiency syndrome. Arch Pathol Lab Med. 1985;109:765–767. [PubMed] [Google Scholar]
- 86.Staroverov VV, Kisel AT, Sumarokov UA, Kachanova TN. A case of phlegmonous gastritis diagnosed by echography. Eur J Ultrasound. 2001;13:197–200. doi: 10.1016/s0929-8266(01)00132-x. [DOI] [PubMed] [Google Scholar]
- 87.Binmoeller KF, Benner KG. Emphysematous gastritis secondary to gastric infarction. Am J Gastroenterol. 1992;87:526–529. [PubMed] [Google Scholar]
- 88.Marshall JB. Tuberculosis of the gastrointestinal tract and peritoneum. Am J Gastroenterol. 1993;88:989–999. [PubMed] [Google Scholar]
- 89.Benson CA. Disease due to the Mycobacterium avium complex in patients with AIDS: Epidemiology and clinical syndrome. Clin Infect Dis. 1994;18(Suppl 3):S218–S222. doi: 10.1093/clinids/18.supplement_3.s218. [DOI] [PubMed] [Google Scholar]
- 90.Berardi RS. Abdominal actinomycosis. Surg Gynecol Obstet. 1979;149:257–266. [PubMed] [Google Scholar]
- 91.Chen CY, Chi KH, George RW. Diagnosis of gastric syphilis by direct immunofluorescence staining and real-time PCR testing. J Clin Microbiol. 2006;44:3452–3456. doi: 10.1128/JCM.00721-06. [DOI] [PMC free article] [PubMed] [Google Scholar]
- 92.Loffeld RJ, Loffeld BC, Arends JW. Fungal colonization of gastric ulcers. Am J Gastroenterol. 1988;83:730–733. [PubMed] [Google Scholar]
- 93.Jayalakshmi P, Goh KL, Soo-Hoo TS, Daud A. Disseminated histoplasmosis presenting as penile ulcer. Austral N Z J Med. 1990;20:175–176. doi: 10.1111/j.1445-5994.1990.tb01298.x. [DOI] [PubMed] [Google Scholar]
- 94.Cherney CL, Chutuape A, Fikrig MK. Fatal invasive gastric mucormycosis occurring with emphysematous gastritis: Case report and literature review. Am J Gastroenterol. 1999;94:252–256. doi: 10.1111/j.1572-0241.1999.00809.x. [DOI] [PubMed] [Google Scholar]
- 95.Forester G, Sidhom O, Nahass R, Andavolu R. AIDS-associated cryptosporidiosis with gastric stricture and a therapeutic response to paromomycin. Am J Gastroenterol. 1994;89:1096–1098. [PubMed] [Google Scholar]
- 96.Garone MA, Winston BJ, Lewis JH. Cryptosporidiosis of the stomach. Am J Gastroenterol. 1986;81:465–470. [PubMed] [Google Scholar]
- 97.Wurtz R, Mirot M, Fronda G. Short report: Gastric infection by Strongyloides stercoralis. Am J Trop Med Hygiene. 1994;51:339–340. doi: 10.4269/ajtmh.1994.51.339. [DOI] [PubMed] [Google Scholar]
- 98.Kim J, Joo HS, Kim DH. A case of gastric strongyloidiasis in a Korean patient. Korean J Parasitol. 2003;41:63–67. doi: 10.3347/kjp.2003.41.1.63. [DOI] [PMC free article] [PubMed] [Google Scholar]
- 99.Choudhuri G, Saha SS, Tandon RK. Gastric ascariasis. Am J Gastroenterol. 1986;81:788–790. [PubMed] [Google Scholar]
- 100.Warren JR, Marshall B. Unidentified curved bacilli on gastric epithelium in active chronic gastritis. Lancet. 1983;321:1273–1275. [PubMed] [Google Scholar]
- 101.Kilbridge PM, Dahms BB, Czinn SJ. Campylobacter pylori–associated gastritis and peptic ulcer disease in children. Am J Dis Child. 1988;142:1149–1152. doi: 10.1001/archpedi.1988.02150110027012. [DOI] [PubMed] [Google Scholar]
- 102.Malaty HM, Evans DG, Evans DJ, Jr, Graham DY. Helicobacter pylori in Hispanics: Comparison with blacks and whites of similar age and socioeconomic class. Gastroenterology. 1992;103:813–816. doi: 10.1016/0016-5085(92)90011-m. [DOI] [PubMed] [Google Scholar]
- 103.Genta RM, Hamner HW. The significance of lymphoid follicles in the interpretation of gastric biopsy specimens. Arch Pathol Lab Med. 1994;118:740–743. [PubMed] [Google Scholar]
- 104.Collins JS, Hamilton PW, Watt PC. Superficial gastritis and Campylobacter pylori in dyspeptic patients: A quantitative study using computer-linked image analysis. J Pathol. 1989;158:303–310. doi: 10.1002/path.1711580407. [DOI] [PubMed] [Google Scholar]
- 105.Amieva MR, El-Omar EM. Host-bacterial interactions in Helicobacter pylori infection. Gastroenterology. 2008;134:306–323. doi: 10.1053/j.gastro.2007.11.009. [DOI] [PubMed] [Google Scholar]
- 106.Niemela S, Karttunen T, Kerola T. Helicobacter pylori-associated gastritis: Evolution of histologic changes over 10 years. Scand J Gastroenterol. 1995;30:542–549. doi: 10.3109/00365529509089787. [DOI] [PubMed] [Google Scholar]
- 107.Tham TCK, Collins JSA, Sloan JM. Long-term effects of Helicobacter pylori on gastric mucosa: An 8 year follow-up. Am J Gastroenterol. 1994;89:1355. [Google Scholar]
- 108.Villako K, Kekki M, Maaroos HI. A 12-year follow-up study of chronic gastritis and Helicobacter pylori in a population-based random sample. Scand J Gastroenterol. 1995;30:964–967. doi: 10.3109/00365529509096339. [DOI] [PubMed] [Google Scholar]
- 109.Heilmann KL, Borchard F. Gastritis due to spiral shaped bacteria other than Helicobacter pylori: Clinical, histological, and ultrastructural findings. Gut. 1991;32:137–140. doi: 10.1136/gut.32.2.137. [DOI] [PMC free article] [PubMed] [Google Scholar]
- 110.Hilzenrat N, Lamoureux E, Weintrub I. Helicobacter heilmannii-like spiral bacteria in gastric mucosal biopsies: Prevalence and clinical significance. Arch Pathol Lab Med. 1995;119:1149–1153. [PubMed] [Google Scholar]
- 111.Morgner A, Lehn N, Andersen LP. Helicobacter heilmannii-associated primary gastric low-grade MALT lymphoma: Complete remission after curing the infection. Gastroenterology. 2000;118:821–828. doi: 10.1016/s0016-5085(00)70167-3. [DOI] [PubMed] [Google Scholar]
- 112.Bentley R, Meganathan R. Biosynthesis of vitamin K (menaquinone) in bacteria. Microbiol Rev. 1982;46:241–280. doi: 10.1128/mr.46.3.241-280.1982. [DOI] [PMC free article] [PubMed] [Google Scholar]
- 113.Hudault S, Guignot J, Servin AL. Escherichia coli strains colonising the gastrointestinal tract protect germfree mice against Salmonella typhimurium infection. Gut. 2001;49:47–55. doi: 10.1136/gut.49.1.47. [DOI] [PMC free article] [PubMed] [Google Scholar]
- 114.Reid G, Howard J, Gan BS. Can bacterial interference prevent infection? Trends Microbiol. 2001;9:424–428. doi: 10.1016/s0966-842x(01)02132-1. [DOI] [PubMed] [Google Scholar]
- 115.Levine MM. Escherichia coli that cause diarrhea: Enterotoxigenic, enteropathogenic, enteroinvasive, enterohemorrhagic, and enteroadherent. J Infect Dis. 1987;155:377–389. doi: 10.1093/infdis/155.3.377. [DOI] [PubMed] [Google Scholar]
- 116.Rothbaum R, McAdams AJ, Giannella R, Partin JC. A clinicopathologic study of enterocyte-adherent Escherichia coli: A cause of protracted diarrhea in infants. Gastroenterology. 1982;83:441–454. [PubMed] [Google Scholar]
- 117.Chuttani HK, Jain K, Misra RC. Small bowel in typhoid fever. Gut. 1971;12:709–712. doi: 10.1136/gut.12.9.709. [DOI] [PMC free article] [PubMed] [Google Scholar]
- 118.Kraus MD, Amatya B, Kimula Y. Histopathology of typhoid enteritis: Morphologic and immunophenotypic findings. Mod Pathol. 1999;12:949–955. [PubMed] [Google Scholar]
- 119.Braunstein H, Tucker EB, Gibson BC. Mesenteric lymphadenitis due to Yersinia enterocolitica: Report of a case. Am J Clin Pathol. 1971;55:506–510. doi: 10.1093/ajcp/55.4.506. [DOI] [PubMed] [Google Scholar]
- 120.El-Maraghi NR, Mair NS. The histopathology of enteric infection with Yersinia pseudotuberculosis. Am J Clin Pathol. 1979;71:631–639. doi: 10.1093/ajcp/71.6.631. [DOI] [PubMed] [Google Scholar]
- 121.Gleason TH, Patterson SD. The pathology of Yersinia enterocolitica ileocolitis. Am J Surg Pathol. 1982;6:347–355. doi: 10.1097/00000478-198206000-00007. [DOI] [PubMed] [Google Scholar]
- 122.Bode RB, Brayton PR, Colwell RR. A new Vibrio species, Vibrio cincinnatiensis, causing meningitis: Successful treatment in an adult. Ann Intern Med. 1986;104:55–56. doi: 10.7326/0003-4819-104-1-55. [DOI] [PubMed] [Google Scholar]
- 123.Brenner DJ, Hickman-Brenner FW, Lee JV. Vibrio furnissii (formerly aerogenic biogroup of Vibrio fluvialis), a new species isolated from human feces and the environment. J Clin Microbiol. 1983;18:816–824. doi: 10.1128/jcm.18.4.816-824.1983. [DOI] [PMC free article] [PubMed] [Google Scholar]
- 124.Davis BR, Fanning GR, Madden JM. Characterization of biochemically atypical Vibrio cholerae strains and designation of a new pathogenic species, Vibrio mimicus. J Clin Microbiol. 1981;14:631–639. doi: 10.1128/jcm.14.6.631-639.1981. [DOI] [PMC free article] [PubMed] [Google Scholar]
- 125.Hickman FW, Farmer JJ, 3rd, Hollis DG. Identification of Vibrio hollisae sp. nov. from patients with diarrhea. J Clin Microbiol. 1982;15:395–401. doi: 10.1128/jcm.15.3.395-401.1982. [DOI] [PMC free article] [PubMed] [Google Scholar]
- 126.Lee JV, Shread P, Furniss AL, Bryant TN. Taxonomy and description of Vibrio fluvialis sp. nov. (synonym group F vibrios, group EF6) J Appl Bacteriol. 1981;50:73–94. doi: 10.1111/j.1365-2672.1981.tb00873.x. [DOI] [PubMed] [Google Scholar]
- 127.Love M, Teebken-Fisher D, Hose JE. Vibrio damsela, a marine bacterium, causes skin ulcers on the damselfish Chromis punctipinnis. Science. 1981;214:1139–1140. doi: 10.1126/science.214.4525.1139. [DOI] [PubMed] [Google Scholar]
- 128.Mathan MM, Chandy G, Mathan VI. Ultrastructural changes in the upper small intestinal mucosa in patients with cholera. Gastroenterology. 1995;109:422–430. doi: 10.1016/0016-5085(95)90329-1. [DOI] [PubMed] [Google Scholar]
- 129.Gui L, Subramony C, Fratkin J, Hughson MD. Fatal enteritis necroticans (pigbel) in a diabetic adult. Mod Pathol. 2002;15:66–70. doi: 10.1038/modpathol.3880491. [DOI] [PubMed] [Google Scholar]
- 130.Matsuda T, Okada Y, Inagi E. Enteritis necroticans ‘pigbel’ in a Japanese diabetic adult. Pathol Int. 2007;57:622–626. doi: 10.1111/j.1440-1827.2007.02149.x. [DOI] [PubMed] [Google Scholar]
- 131.Meinzer U, Esmiol-Welterlin S, Barreau F. Nod2 mediates susceptibility to Yersinia pseudotuberculosis in mice. PLoS ONE. 2008;3:e2769. doi: 10.1371/journal.pone.0002769. [DOI] [PMC free article] [PubMed] [Google Scholar]
- 132.Reed RP, Robins-Browne RM, Williams ML. Yersinia enterocolitica peritonitis. Clin Infect Dis. 1997;25:1468–1469. doi: 10.1086/516122. [DOI] [PubMed] [Google Scholar]
- 133.de Cuenca-Moron B, Solis-Herruzo JA, Moreno D. Spontaneous bacterial peritonitis due to Yersinia enterocolitica in secondary alcoholic hemochromatosis. J Clin Gastroenterol. 1989;11:675–678. doi: 10.1097/00004836-198912000-00016. [DOI] [PubMed] [Google Scholar]
- 134.Capron JP, Capron-Chivrac D, Tossou H. Spontaneous Yersinia enterocolitica peritonitis in idiopathic hemochromatosis. Gastroenterology. 1984;87:1372–1375. [PubMed] [Google Scholar]
- 135.Cianciulli P, Trua G, Papa G. Yersinia enterocolitica mesenteric adenitis in a thalassaemic adolescent: Conservative management. Eur J Pediatr. 1992;151:145–146. doi: 10.1007/BF01958962. [DOI] [PubMed] [Google Scholar]
- 136.Gallant T, Freedman MH, Vellend H, Francombe WH. Yersinia sepsis in patients with iron overload treated with deferoxamine. N Engl J Med. 1986;314:1643. doi: 10.1056/NEJM198606193142515. [DOI] [PubMed] [Google Scholar]
- 137.Green NS. Yersinia infections in patients with homozygous beta-thalassemia associated with iron overload and its treatment. Pediatr Hematol Oncol. 1992;9:247–254. doi: 10.3109/08880019209016592. [DOI] [PubMed] [Google Scholar]
- 138.Cohen JI, Rodday P. Yersinia enterocolitica bacteremia in a patient with the acquired immunodeficiency syndrome. Am J Med. 1989;86:254–255. doi: 10.1016/0002-9343(89)90285-4. [DOI] [PubMed] [Google Scholar]
- 139.Boemi G, Chiesa C, Di Lorenzo M. Yersinia enterocolitica peritonitis. Gastroenterology. 1985;89:927–928. doi: 10.1016/0016-5085(85)90611-0. [DOI] [PubMed] [Google Scholar]
- 140.Brubaker RR. Factors promoting acute and chronic diseases caused by yersiniae. Clin Microbiol Rev. 1991;4:309–324. doi: 10.1128/cmr.4.3.309. [DOI] [PMC free article] [PubMed] [Google Scholar]
- 141.Autenrieth IB, Firsching R. Penetration of M cells and destruction of Peyer's patches by Yersinia enterocolitica: An ultrastructural and histological study. J Med Microbiol. 1996;44:285–294. doi: 10.1099/00222615-44-4-285. [DOI] [PubMed] [Google Scholar]
- 142.Clark MA, Hirst BH, Jepson MA. M-cell surface beta1 integrin expression and invasin-mediated targeting of Yersinia pseudotuberculosis to mouse Peyer's patch M cells. Infect Immun. 1998;66:1237–1243. doi: 10.1128/iai.66.3.1237-1243.1998. [DOI] [PMC free article] [PubMed] [Google Scholar]
- 143.Handley SA, Dube PH, Revell PA, Miller VL. Characterization of oral Yersinia enterocolitica infection in three different strains of inbred mice. Infect Immun. 2004;72:1645–1656. doi: 10.1128/IAI.72.3.1645-1656.2004. [DOI] [PMC free article] [PubMed] [Google Scholar]
- 144.Tuohy AM, O’Gorman M, Byington C. Yersinia enterocolitis mimicking Crohn's disease in a toddler. Pediatrics. 1999;104:e36. doi: 10.1542/peds.104.3.e36. [DOI] [PubMed] [Google Scholar]
- 145.Gold BD, Westra SJ, Graeme-Cook FM. Case records of the Massachusetts General Hospital: Weekly clinicopathological exercises. Case 40-2003: A 14-month-old boy with recurrent abdominal distention and diarrhea. N Engl J Med. 2003;349:2541–2549. doi: 10.1056/NEJMcpc030030. [DOI] [PubMed] [Google Scholar]
- 146.Anand SS. Hypertrophic ileo-caecal tuberculosis in India with a record of fifty hemicolectomies. Ann R Coll Surg Engl. 1956;19:205–222. [PMC free article] [PubMed] [Google Scholar]
- 147.Hsieh SM, Hung CC, Chen MY. Clinical features and outcome in disseminated mycobacterial diseases in AIDS patients in Taiwan. AIDS. 1998;12:1301–1307. doi: 10.1097/00002030-199811000-00011. [DOI] [PubMed] [Google Scholar]
- 148.Chaisson RE, Gallant JE, Keruly JC, Moore RD. Impact of opportunistic disease on survival in patients with HIV infection. AIDS. 1998;12:29–33. doi: 10.1097/00002030-199801000-00004. [DOI] [PubMed] [Google Scholar]
- 149.Palella FJ, Jr, Delaney KM, Moorman AC. Declining morbidity and mortality among patients with advanced human immunodeficiency virus infection. HIV Outpatient Study Investigators. N Engl J Med. 1998;338:853–860. doi: 10.1056/NEJM199803263381301. [DOI] [PubMed] [Google Scholar]
- 150.Horsburgh CR., Jr The pathophysiology of disseminated Mycobacterium avium complex disease in AIDS. J Infect Dis. 1999;179(Suppl 3):S461–S465. doi: 10.1086/314804. [DOI] [PubMed] [Google Scholar]
- 151.Horsburgh C. Mycobacterial disease of the gastrointestinal tract. In: Blaser M, Amith P, Ravdin JI, editors. Infections of the Gastrointestinal Tract. Raven Press; New York: 1995. pp. 937–955. [Google Scholar]
- 152.Sun HY, Chen MY, Wu MS. Endoscopic appearance of GI mycobacteriosis caused by the Mycobacterium avium complex in a patient with AIDS: Case report and review. Gastrointest Endosc. 2005;61:775–779. doi: 10.1016/s0016-5107(04)02786-5. [DOI] [PubMed] [Google Scholar]
- 153.Rotterdam H, Tsang P. Gastrointestinal disease in the immunocompromised patient. Hum Pathol. 1994;25:1123–1140. doi: 10.1016/0046-8177(94)90029-9. [DOI] [PubMed] [Google Scholar]
- 154.Fenollar F, Puechal X, Raoult D. Whipple's disease. N Engl J Med. 2007;356:55–66. doi: 10.1056/NEJMra062477. [DOI] [PubMed] [Google Scholar]
- 155.Fenollar F, Lepidi H, Gerolami R. Whipple disease associated with giardiasis. J Infect Dis. 2003;188:828–834. doi: 10.1086/378093. [DOI] [PubMed] [Google Scholar]
- 156.Marth T, Strober W. Whipple's disease. Semin Gastrointest Dis. 1996;7:41–48. [PubMed] [Google Scholar]
- 157.Marth T, Neurath M, Cuccherini BA, Strober W. Defects of monocyte interleukin 12 production and humoral immunity in Whipple's disease. Gastroenterology. 1997;113:442–448. doi: 10.1053/gast.1997.v113.pm9247462. [DOI] [PubMed] [Google Scholar]
- 158.Elssner A, Doseff AI, Duncan M. IL-16 is constitutively present in peripheral blood monocytes and spontaneously released during apoptosis. J Immunol. 2004;172:7721–7725. doi: 10.4049/jimmunol.172.12.7721. [DOI] [PubMed] [Google Scholar]
- 159.Puechal X. Whipple disease and arthritis. Curr Opin Rheumatol. 2001;13:74–79. doi: 10.1097/00002281-200101000-00012. [DOI] [PubMed] [Google Scholar]
- 160.Gerard A, Sarrot-Reynauld F, Liozon E. Neurologic presentation of Whipple disease: Report of 12 cases and review of the literature. Medicine (Baltimore) 2002;81:443–457. doi: 10.1097/00005792-200211000-00005. [DOI] [PubMed] [Google Scholar]
- 161.Mahnel R, Kalt A, Ring S. Immunosuppressive therapy in Whipple's disease patients is associated with the appearance of gastrointestinal manifestations. Am J Gastroenterol. 2005;100:1167–1173. doi: 10.1111/j.1572-0241.2005.40128.x. [DOI] [PubMed] [Google Scholar]
- 162.Dobbins WI. Charles C Thomas; Springfield, Ill.: 1987. Whipple's Disease. [Google Scholar]
- 163.Marth T, Raoult D. Whipple's disease. Lancet. 2003;361:239–246. doi: 10.1016/S0140-6736(03)12274-X. [DOI] [PubMed] [Google Scholar]
- 164.von Herbay A, Maiwald M, Ditton HJ, Otto HF. Histology of intestinal Whipple's disease revisited: A study of 48 patients. Virchows Arch. 1996;429:335–343. doi: 10.1007/BF00198437. [DOI] [PubMed] [Google Scholar]
- 165.Fenollar F, Raoult D. Whipple's disease. Clin Diagn Lab Immunol. 2001;8:1–8. doi: 10.1128/CDLI.8.1.1-8.2001. [DOI] [PMC free article] [PubMed] [Google Scholar]
- 166.Dutly F, Altwegg M. Whipple's disease and “Tropheryma whippelii.”. Clin Microbiol Rev. 2001;14:561–583. doi: 10.1128/CMR.14.3.561-583.2001. [DOI] [PMC free article] [PubMed] [Google Scholar]
- 167.Owens SR, Greenson JK. The pathology of malabsorption: Current concepts. Histopathology. 2007;50:64–82. doi: 10.1111/j.1365-2559.2006.02547.x. [DOI] [PubMed] [Google Scholar]
- 168.Peetermans WE, Vonck A. Tropical sprue after travel to Tanzania. J Travel Med. 2000;7:33–34. doi: 10.2310/7060.2000.00009. [DOI] [PubMed] [Google Scholar]
- 169.Guerra R, Wheby MS, Bayless TM. Long-term antibiotic therapy in tropical sprue. Ann Intern Med. 1965;63:619–634. doi: 10.7326/0003-4819-63-4-619. [DOI] [PubMed] [Google Scholar]
- 170.Ghoshal UC, Ghoshal U, Ayyagari A. Tropical sprue is associated with contamination of small bowel with aerobic bacteria and reversible prolongation of orocecal transit time. J Gastroenterol Hepatol. 2003;18:540–547. doi: 10.1046/j.1440-1746.2003.03006.x. [DOI] [PubMed] [Google Scholar]
- 171.Day D, Jass J, Price AB. Blackwell; Malden, Mass.: 2003. Morson and Dawson's Gastrointesitnal Pathology. [Google Scholar]
- 172.Robert M. Inflammatory disorders of the small intestine. In: Odze R, Goldblum J, Crawford J, editors. Surgical Pathology of the Gastrointestinal Tract, Liver, Biliary Tract, and Pancreas. Saunders; Philadelphia: 2004. pp. 117–212. [Google Scholar]
- 173.Schenk EA, Samloff IM, Klipstein FA. Morphologic characteristics of jejunal biopsy in celiac disease and tropical sprue. Am J Pathol. 1965;47:765–781. [PMC free article] [PubMed] [Google Scholar]
- 174.Swanson VL, Thomassen RW. Pathology of the jejunal mucosa in tropical sprue. Am J Pathol. 1965;46:511–551. [PMC free article] [PubMed] [Google Scholar]
- 175.Wheby MS, Swanson VL, Bayless TM. Comparison of ileal and jejunal biopsies in tropical sprue. Am J Clin Nutr. 1971;24:117–123. doi: 10.1093/ajcn/24.1.117. [DOI] [PubMed] [Google Scholar]
- 176.Prescott RJ, Harris M, Banerjee SS. Fungal infections of the small and large intestine. J Clin Pathol. 1992;45:806–811. doi: 10.1136/jcp.45.9.806. [DOI] [PMC free article] [PubMed] [Google Scholar]
- 177.Cappell MS, Mandell W, Grimes MM, Neu HC. Gastrointestinal histoplasmosis. Dig Dis Sci. 1988;33:353–360. doi: 10.1007/BF01535762. [DOI] [PubMed] [Google Scholar]
- 178.Bodily K, Perfect JR, Procop G. Small intestinal histoplasmosis: Successful treatment with itraconazole in an immunocompetent host. Gastrointest Endosc. 1996;43:518–521. doi: 10.1016/s0016-5107(96)70300-0. [DOI] [PubMed] [Google Scholar]
- 179.Halline AG, Maldonado-Lutomirsky M, Ryoo JW. Colonic histoplasmosis in AIDS: Unusual endoscopic findings in two cases. Gastrointest Endosc. 1997;45:199–204. doi: 10.1016/s0016-5107(97)70252-9. [DOI] [PubMed] [Google Scholar]
- 180.Eras P, Goldstein MJ, Sherlock P. Candida infection of the gastrointestinal tract. Medicine (Baltimore) 1972;51:367–379. doi: 10.1097/00005792-197209000-00002. [DOI] [PubMed] [Google Scholar]
- 181.Leung WK, To KF, Chan PK. Enteric involvement of severe acute respiratory syndrome-associated coronavirus infection. Gastroenterology. 2003;125:1011–1017. doi: 10.1016/j.gastro.2003.08.001. [DOI] [PMC free article] [PubMed] [Google Scholar]
- 182.Walter JE, Mitchell DK. Astrovirus infection in children. Curr Opin Infect Dis. 2003;16:247–253. doi: 10.1097/00001432-200306000-00011. [DOI] [PubMed] [Google Scholar]
- 183.Vernacchio L, Vezina RM, Mitchell AA. Diarrhea in American infants and young children in the community setting: Incidence, clinical presentation and microbiology. Pediatr Infect Dis J. 2006;25:2–7. doi: 10.1097/01.inf.0000195623.57945.87. [DOI] [PubMed] [Google Scholar]
- 184.Chamberlain RS, Atkins S, Saini N, White JC. Ileal perforation caused by cytomegalovirus infection in a critically ill adult. J Clin Gastroenterol. 2000;30:432–435. doi: 10.1097/00004836-200006000-00016. [DOI] [PubMed] [Google Scholar]
- 185.Abu-Elmagd KM, Tzakis A, Todo S. Monitoring and treatment of intestinal allograft rejection in humans. Transplant Proc. 1993;25(1 Pt 2):1202–1203. [PMC free article] [PubMed] [Google Scholar]
- 186.Manez R, Kusne S, Abu-Elmagd K. Factors associated with recurrent cytomegalovirus disease after small bowel transplantation. Transplant Proc. 1994;26:1422–1423. [PMC free article] [PubMed] [Google Scholar]
- 187.Kusne S, Manez R, Frye BL. Use of DNA amplification for diagnosis of cytomegalovirus enteritis after intestinal transplantation. Gastroenterology. 1997;112:1121–1128. doi: 10.1016/s0016-5085(97)70122-7. [DOI] [PubMed] [Google Scholar]
- 188.Keates J, Lagahee S, Crilley P. CMV enteritis causing segmental ischemia and massive intestinal hemorrhage. Gastrointest Endosc. 2001;53:355–359. doi: 10.1016/s0016-5107(01)70417-8. [DOI] [PubMed] [Google Scholar]
- 189.Peterson PK, Balfour HH, Jr, Marker SC. Cytomegalovirus disease in renal allograft recipients: A prospective study of the clinical features, risk factors and impact on renal transplantation. Medicine (Baltimore) 1980;59:283–300. [PubMed] [Google Scholar]
- 190.Page MJ, Dreese JC, Poritz LS, Koltun WA. Cytomegalovirus enteritis: A highly lethal condition requiring early detection and intervention. Dis Colon Rectum. 1998;41:619–623. doi: 10.1007/BF02235271. [DOI] [PubMed] [Google Scholar]
- 191.Teixidor HS, Honig CL, Norsoph E. Cytomegalovirus infection of the alimentary canal: Radiologic findings with pathologic correlation. Radiology. 1987;163:317–323. doi: 10.1148/radiology.163.2.3031723. [DOI] [PubMed] [Google Scholar]
- 192.Kotler DP, Shimada T, Snow G. Effect of combination antiretroviral therapy upon rectal mucosal HIV RNA burden and mononuclear cell apoptosis. AIDS. 1998;12:97–604. doi: 10.1097/00002030-199806000-00008. [DOI] [PubMed] [Google Scholar]
- 193.Clayton F, Kotler DP, Kuwada SK. Gp120-induced Bob/GPR15 activation: A possible cause of human immunodeficiency virus enteropathy. Am J Pathol. 2001;159:1933–1939. doi: 10.1016/S0002-9440(10)63040-4. [DOI] [PMC free article] [PubMed] [Google Scholar]
- 194.Dayanithi G, Yahi N, Baghdiguian S, Fantini J. Intracellular calcium release induced by human immunodeficiency virus type 1 (HIV-1) surface envelope glycoprotein in human intestinal epithelial cells: A putative mechanism for HIV-1 enteropathy. Cell Calcium. 1995;18:9–18. doi: 10.1016/0143-4160(95)90041-1. [DOI] [PubMed] [Google Scholar]
- 195.Maresca M, Mahfoud R, Garmy N. The virotoxin model of HIV-1 enteropathy: Involvement of GPR15/Bob and galactosylceramide in the cytopathic effects induced by HIV-1 gp120 in the HT-29-D4 intestinal cell line. J Biomed Sci. 2003;10:156–166. doi: 10.1007/BF02256007. [DOI] [PubMed] [Google Scholar]
- 196.Schmitz H, Rokos K, Florian P. Supernatants of HIV-infected immune cells affect the barrier function of human HT-29/B6 intestinal epithelial cells. AIDS. 2002;16:983–991. doi: 10.1097/00002030-200205030-00004. [DOI] [PubMed] [Google Scholar]
- 197.Stockmann M, Fromm M, Schmitz H. Duodenal biopsies of HIV-infected patients with diarrhoea exhibit epithelial barrier defects but no active secretion. AIDS. 1998;12:43–51. doi: 10.1097/00002030-199801000-00006. [DOI] [PubMed] [Google Scholar]
- 198.Chui DW, Owen RL. AIDS and the gut. J Gastroenterol Hepatol. 1994;9:291–303. doi: 10.1111/j.1440-1746.1994.tb01729.x. [DOI] [PubMed] [Google Scholar]
- 199.Delezay O, Yahi N, Tamalet C. Direct effect of type 1 human immunodeficiency virus (HIV-1) on intestinal epithelial cell differentiation: Relationship to HIV-1 enteropathy. Virology. 1997;238:231–242. doi: 10.1006/viro.1997.8829. [DOI] [PubMed] [Google Scholar]
- 200.Greenson JK, Belitsos PC, Yardley JH, Bartlett JG. AIDS enteropathy: Occult enteric infections and duodenal mucosal alterations in chronic diarrhea. Ann Intern Med. 1991;114:366–372. doi: 10.7326/0003-4819-114-5-366. [DOI] [PubMed] [Google Scholar]
- 201.Clayton F, Clayton CH. Gastrointestinal pathology in HIV-infected patients. Gastroenterol Clin North Am. 1997;26:191–240. doi: 10.1016/s0889-8553(05)70293-4. [DOI] [PubMed] [Google Scholar]
- 202.Farthing MJ, Kelly MP, Veitch AM. Recently recognised microbial enteropathies and HIV infection. J Antimicrob Chemother. 1996;37(Suppl B):61–70. doi: 10.1093/jac/37.suppl_b.61. [DOI] [PubMed] [Google Scholar]
- 203.Farthing MJ. The molecular pathogenesis of giardiasis. J Pediatr Gastroenterol Nutr. 1997;24:79–88. doi: 10.1097/00005176-199701000-00018. [DOI] [PubMed] [Google Scholar]
- 204.Hill DR. Giardiasis. Issues in diagnosis and management. Infect Dis Clin North Am. 1993;7:503–525. [PubMed] [Google Scholar]
- 205.Feely DE, Gardner MD, Hardin EL. Excystation of Giardia muris induced by a phosphate-bicarbonate medium: Localization of acid phosphatase. J Parasitol. 1991;77:441–448. [PubMed] [Google Scholar]
- 206.Erlandsen SL, Chase DG. Morphological alterations in the microvillous border of villous epithelial cells produced by intestinal microorganisms. Am J Clin Nutr. 1974;27:1277–1286. doi: 10.1093/ajcn/27.11.1277. [DOI] [PubMed] [Google Scholar]
- 207.Oberhuber G, Stolte M. Giardiasis: Analysis of histological changes in biopsy specimens of 80 patients. J Clin Pathol. 1990;43:641–643. doi: 10.1136/jcp.43.8.641. [DOI] [PMC free article] [PubMed] [Google Scholar]
- 208.Oberhuber G, Kastner N, Stolte M. Giardiasis: A histologic analysis of 567 cases. Scand J Gastroenterol. 1997;32:48–51. doi: 10.3109/00365529709025062. [DOI] [PubMed] [Google Scholar]
- 209.Wright SG, Tomkins AM. Quantification of the lymphocytic infiltrate in jejunal epithelium in giardiasis. Clin Exp Immunol. 1977;29:408–412. [PMC free article] [PubMed] [Google Scholar]
- 210.Rosekrans PC, Lindeman J, Meijer CJ. Quantitative histological and immunohistochemical findings in jejunal biopsy specimens in giardiasis. Virchows Arch A Pathol Anat Histol. 1981;393:145–151. doi: 10.1007/BF00431071. [DOI] [PubMed] [Google Scholar]
- 211.Huang DB, Chappell C, Okhuysen PC. Cryptosporidiosis in children. Semin Pediatr Infect Dis. 2004;15:253–259. doi: 10.1053/j.spid.2004.07.006. [DOI] [PubMed] [Google Scholar]
- 212.Goodgame RW. Understanding intestinal spore-forming protozoa: Cryptosporidia, microsporidia, isospora, and cyclospora. Ann Intern Med. 1996;124:429–441. doi: 10.7326/0003-4819-124-4-199602150-00008. [DOI] [PubMed] [Google Scholar]
- 213.Lewthwaite P, Gill GV, Hart CA, Beeching NJ. Gastrointestinal parasites in the immunocompromised. Curr Opin Infect Dis. 2005;18:427–435. doi: 10.1097/01.qco.0000182104.40128.18. [DOI] [PubMed] [Google Scholar]
- 214.Rabeneck L, Gyorkey F, Genta RM. The role of microsporidia in the pathogenesis of HIV-related chronic diarrhea. Ann Intern Med. 1993;119:895–899. doi: 10.7326/0003-4819-119-9-199311010-00005. [DOI] [PubMed] [Google Scholar]
- 215.Beauvais B, Sarfati C, Molina JM. Comparative evaluation of five diagnostic methods for demonstrating microsporidia in stool and intestinal biopsy specimens. Ann Trop Med Parasitol. 1993;87:99–102. doi: 10.1080/00034983.1993.11812742. [DOI] [PubMed] [Google Scholar]
- 216.Curry A, Smith HV. Emerging pathogens: Isospora, Cyclospora and microsporidia. Parasitology. 1998;117(Suppl):S143–S159. doi: 10.1017/s0031182099004904. [DOI] [PubMed] [Google Scholar]
- 217.Connor BA, Reidy J, Soave R. Cyclosporiasis: Clinical and histopathologic correlates. Clin Infect Dis. 1999;28:1216–1222. doi: 10.1086/514780. [DOI] [PubMed] [Google Scholar]
- 218.Cook GC. The clinical significance of gastrointestinal helminths: A review. Trans R Soc Trop Med Hyg. 1986;80:675–685. doi: 10.1016/0035-9203(86)90366-4. [DOI] [PubMed] [Google Scholar]
- 219.Neafie RC, Conner DH, Cross HH, Meyers WH. Diseases caused by other nematodes. In: Binford CH, Connor DH, editors. vol. 2. The Armed Forces Institute of Pathology; Washington, DC: 1976. pp. 397–481. (Pathology of Tropical and Extraordinary Disease). [Google Scholar]
- 220.Bundy DA, Cooper ES, Thompson DE. Epidemiology and population dynamics of Ascaris lumbricoides and Trichuris trichiura infection in the same community. Trans R Soc Trop Med Hyg. 1987;81:987–993. doi: 10.1016/0035-9203(87)90372-5. [DOI] [PubMed] [Google Scholar]
- 221.Cooper ES, Whyte-Alleng CA, Finzi-Smith JS, MacDonald TT. Intestinal nematode infections in children: The pathophysiological price paid. Parasitology. 1992;104(Suppl):S91–S103. doi: 10.1017/s0031182000075272. [DOI] [PubMed] [Google Scholar]
- 222.Croese J, Loukas A, Opdebeeck J. Human enteric infection with canine hookworms. Ann Intern Med. 1994;120:369–374. doi: 10.7326/0003-4819-120-5-199403010-00003. [DOI] [PubMed] [Google Scholar]
- 223.Milder JE, Walzer PD, Kilgore G. Clinical features of Strongyloides stercoralis infection in an endemic area of the United States. Gastroenterology. 1981;80:1481–1488. [PubMed] [Google Scholar]
- 224.Concha R, Harrington W, Jr, Rogers AI. Intestinal strongyloidiasis: Recognition, management, and determinants of outcome. J Clin Gastroenterol. 2005;39:203–211. doi: 10.1097/01.mcg.0000152779.68900.33. [DOI] [PubMed] [Google Scholar]
- 225.Keiser PB, Nutman TB. Strongyloides stercoralis in the immunocompromised population. Clin Microbiol Rev. 2004;17:208–217. doi: 10.1128/CMR.17.1.208-217.2004. [DOI] [PMC free article] [PubMed] [Google Scholar]
- 226.Ramdial PK, Hlatshwayo NH, Singh B. Strongyloides stercoralis mesenteric lymphadenopathy: Clue to the etiopathogenesis of intestinal pseudo-obstruction in HIV-infected patients. Ann Diagn Pathol. 2006;10:209–214. doi: 10.1016/j.anndiagpath.2005.11.008. [DOI] [PubMed] [Google Scholar]
- 227.Longworth DL, Weller PF. Hyperinfection syndrome in strongyloidiasis. In: Remington JS, Swartz MN, editors. Current Clinical Topics in Infectious Diseases. McGraw-Hill; New York: 1986. pp. 1–7. [Google Scholar]
- 228.Scaglia M, Brustia R, Gatti S. Autochthonous strongyloidiasis in Italy: An epidemiological and clinical review of 150 cases. Bull Soc Pathol Exot Filiales. 1984;77:328–332. [PubMed] [Google Scholar]
- 229.Genta RM, Weesner R, Douce RW. Strongyloidiasis in US veterans of the Vietnam and other wars. JAMA. 1987;258:49–52. [PubMed] [Google Scholar]
- 230.Rivasi F, Pampiglione S, Boldorini R, Cardinale L. Histopathology of gastric and duodenal Strongyloides stercoralis locations in fifteen immunocompromised subjects. Arch Pathol Lab Med. 2006;130:1792–1798. doi: 10.5858/2006-130-1792-HOGADS. [DOI] [PubMed] [Google Scholar]
- 231.Dronda F, Chaves F, Sanz A, Lopez-Velez R. Human intestinal capillariasis in an area of nonendemicity: Case report and review. Clin Infect Dis. 1993;17:909–912. doi: 10.1093/clinids/17.5.909. [DOI] [PubMed] [Google Scholar]
- 232.Cross JH. Intestinal capillariasis. Clin Microbiol Rev. 1992;5:120–129. doi: 10.1128/cmr.5.2.120. [DOI] [PMC free article] [PubMed] [Google Scholar]
- 233.Neafie RC, Connor DH. Fasciolopsiasis. In: Binford CH, Connor DH, editors. Vol. 2. The Armed Forces Institute of Pathology; Washington, DC: 1976. pp. 528–529. (Pathology of Tropical and Extraordinary Diseases). [Google Scholar]
- 234.Liu LX, Harinasuta KT. Liver and intestinal flukes. Gastroenterol Clin North Am. 1996;25:627–636. doi: 10.1016/s0889-8553(05)70266-1. [DOI] [PubMed] [Google Scholar]
- 235.Chai JY, Darwin Murrell K, Lymbery AJ. Fish-borne parasitic zoonoses: Status and issues. Int J Parasitol. 2005;35:1233–1254. doi: 10.1016/j.ijpara.2005.07.013. [DOI] [PubMed] [Google Scholar]
- 236.Fried B, Graczyk TK, Tamang L. Food-borne intestinal trematodiases in humans. Parasitol Res. 2004;93:159–170. doi: 10.1007/s00436-004-1112-x. [DOI] [PubMed] [Google Scholar]
- 237.Park CI, Kim H, Ro JY, Gutierrez Y. Human ectopic fascioliasis in the cecum. Am J Surg Pathol. 1984;8:73–77. doi: 10.1097/00000478-198401000-00008. [DOI] [PubMed] [Google Scholar]
- 238.Despommier DD. Tapeworm infection: The long and the short of it. N Engl J Med. 1992;327:727–728. doi: 10.1056/NEJM199209033271011. [DOI] [PubMed] [Google Scholar]
- 239.Bruckner DA. Helminthic food-borne infections. Clin Lab Med. 1999;19:639–660. [PubMed] [Google Scholar]
- 240.Levine MM, Levine OS. Changes in human ecology and behavior in relation to the emergence of diarrheal diseases, including cholera. Proc Natl Acad Sci U S A. 1994;91:2390–2394. doi: 10.1073/pnas.91.7.2390. [DOI] [PMC free article] [PubMed] [Google Scholar]
- 241.Nostrant TT, Kumar NB, Appelman HD. Histopathology differentiates acute self-limited colitis from ulcerative colitis. Gastroenterology. 1987;92:318–328. doi: 10.1016/0016-5085(87)90124-7. [DOI] [PubMed] [Google Scholar]
- 242.Surawicz CM. The role of rectal biopsy in infectious colitis. Am J Surg Pathol. 1988;12(Suppl 1):82–88. [PubMed] [Google Scholar]
- 243.Surawicz CM, Belic L. Rectal biopsy helps to distinguish acute self-limited colitis from idiopathic inflammatory bowel disease. Gastroenterology. 1984;86:104–113. [PubMed] [Google Scholar]
- 244.Echeverria P, Savarino SJ, Yamamoto T. Escherichia coli diarrhoea. Bailliere Clin Gastroenterol. 1993;7:243–262. doi: 10.1016/0950-3528(93)90042-q. [DOI] [PubMed] [Google Scholar]
- 245.Adachi JA, Jiang ZD, Mathewson JJ. Enteroaggregative Escherichia coli as a major etiologic agent in traveler's diarrhea in 3 regions of the world. Clin Infect Dis. 2001;32:1706–1709. doi: 10.1086/320756. [DOI] [PubMed] [Google Scholar]
- 246.Edelman R, Karmali MA, Fleming PA. From the National Institutes of Health. Summary of the International Symposium and Workshop on Infections due to Verocytotoxin (Shiga-like toxin)-producing Escherichia coli. J Infect Dis. 1988;157:1102–1104. doi: 10.1093/infdis/157.5.1102. [DOI] [PubMed] [Google Scholar]
- 247.Phillips AD, Navabpour S, Hicks S. Enterohaemorrhagic Escherichia coli O157 : H7 target Peyer's patches in humans and cause attaching/effacing lesions in both human and bovine intestine. Gut. 2000;47:377–381. doi: 10.1136/gut.47.3.377. [DOI] [PMC free article] [PubMed] [Google Scholar]
- 248.Tarr PI, Neill MA, Clausen CR. Genotypic variation in pathogenic Escherichia coli O157 : H7 isolated from patients in Washington, 1984-1987. J Infect Dis. 1989;159:344–347. doi: 10.1093/infdis/159.2.344. [DOI] [PubMed] [Google Scholar]
- 249.Griffin PM, Olmstead LC, Petras RE. Escherichia coli O157 : H7-associated colitis: A clinical and histological study of 11 cases. Gastroenterology. 1990;99:142–149. doi: 10.1016/0016-5085(90)91241-w. [DOI] [PubMed] [Google Scholar]
- 250.Hunt CM, Harvey JA, Youngs ER. Clinical and pathological variability of infection by enterohaemorrhagic (Vero cytotoxin producing) Escherichia coli. J Clin Pathol. 1989;42:847–852. doi: 10.1136/jcp.42.8.847. [DOI] [PMC free article] [PubMed] [Google Scholar]
- 251.Lee SD, Surawicz CM. Infectious causes of chronic diarrhea. Gastroenterol Clin North Am. 2001;30:679–692. doi: 10.1016/s0889-8553(05)70205-3. viii. [DOI] [PubMed] [Google Scholar]
- 252.Siegal D, Syed F, Hamid N, Cunha BA. Campylobacter jejuni pancolitis mimicking idiopathic ulcerative colitis. Heart Lung. 2005;34:288–290. doi: 10.1016/j.hrtlng.2004.10.003. [DOI] [PubMed] [Google Scholar]
- 253.Schneider EN, Havens JM, Scott MA. Molecular diagnosis of Campylobacter jejuni infection in cases of focal active colitis. Am J Surg Pathol. 2006;30:782–785. doi: 10.1097/00000478-200606000-00017. [DOI] [PubMed] [Google Scholar]
- 254.Anderson JB, Tanner AH, Brodribb AJ. Toxic megacolon due to Campylobacter colitis. Int J Colorectal Dis. 1986;1:58–59. doi: 10.1007/BF01648839. [DOI] [PubMed] [Google Scholar]
- 255.Butzler JP. Campylobacter, from obscurity to celebrity. Clin Microbiol Infect. 2004;10:868–876. doi: 10.1111/j.1469-0691.2004.00983.x. [DOI] [PubMed] [Google Scholar]
- 256.Price AB, Davies DR. Pseudomembranous colitis. J Clin Pathol. 1977;30:1–12. doi: 10.1136/jcp.30.1.1. [DOI] [PMC free article] [PubMed] [Google Scholar]
- 257.Schiffman R. Signet-ring cells associated with pseudomembranous colitis. Am J Surg Pathol. 1996;20:599–602. doi: 10.1097/00000478-199605000-00006. [DOI] [PubMed] [Google Scholar]
- 258.Chatzicostas C, Koutroubakis IE, Tzardi M. Colonic tuberculosis mimicking Crohn's disease: Case report. BMC Gastroenterol. 2002;2:10. doi: 10.1186/1471-230X-2-10. [DOI] [PMC free article] [PubMed] [Google Scholar]
- 259.Calderaro A, Bommezzadri S, Gorrini C. Infective colitis associated with human intestinal spirochetosis. J Gastroenterol Hepatol. 2007;22:1772–1779. doi: 10.1111/j.1440-1746.2006.04606.x. [DOI] [PubMed] [Google Scholar]
- 260.Christie JD. Intestinal spirochetes: Organisms in search of a disease? Am J Clin Pathol. 2003;120:820–821. doi: 10.1309/WDHX-RXMT-RB2P-M1J2. [DOI] [PubMed] [Google Scholar]
- 261.van Mook WN, Koek GH, van der Ven AJ. Human intestinal spirochaetosis: Any clinical significance? Eur J Gastroenterol Hepatol. 2004;16:83–87. doi: 10.1097/00042737-200401000-00013. [DOI] [PubMed] [Google Scholar]
- 262.Ho M. Epidemiology of cytomegalovirus infections. Rev Infect Dis. 1990;12(Suppl 7):S701–S710. doi: 10.1093/clinids/12.supplement_7.s701. [DOI] [PubMed] [Google Scholar]
- 263.Kyriazis AP, Mitra SK. Multiple cytomegalovirus-related intestinal perforations in patients with acquired immunodeficiency syndrome: Report of two cases and review of the literature. Arch Pathol Lab Med. 1992;116:495–499. [PubMed] [Google Scholar]
- 264.Kambham N, Vij R, Cartwright CA, Longacre T. Cytomegalovirus infection in steroid-refractory ulcerative colitis: A case-control study. Am J Surg Pathol. 2004;28:365–373. doi: 10.1097/00000478-200403000-00009. [DOI] [PubMed] [Google Scholar]
- 265.Surawicz CM, Goodell SE, Quinn TC. Spectrum of rectal biopsy abnormalities in homosexual men with intestinal symptoms. Gastroenterology. 1986;91:651–659. doi: 10.1016/0016-5085(86)90635-9. [DOI] [PubMed] [Google Scholar]
- 266.Haque R, Huston CD, Hughes M. Amebiasis. N Engl J Med. 2003;348:1565–1573. doi: 10.1056/NEJMra022710. [DOI] [PubMed] [Google Scholar]
- 267.Castro J, Vazquez-Iglesias JL, Arnal-Monreal F. Dysentery caused by Balantidium coli: Report of two cases. Endoscopy. 1983;15:272–274. doi: 10.1055/s-2007-1021531. [DOI] [PubMed] [Google Scholar]
- 268.Matsumoto T, Iida M, Kimura Y. Anisakiasis of the colon: Radiologic and endoscopic features in six patients. Radiology. 1992;183:97–99. doi: 10.1148/radiology.183.1.1549697. [DOI] [PubMed] [Google Scholar]
- 269.Nash TE, Cheever AW, Ottesen EA, Cook JA. Schistosome infections in humans: Perspectives and recent findings. NIH conference. Ann Intern Med. 1982;97:740–754. doi: 10.7326/0003-4819-97-5-740. [DOI] [PubMed] [Google Scholar]
- 270.Lemos LB, Qu Z, Laucirica R, Fred HL. Hyperinfection syndrome in strongyloidiasis: Report of two cases. Ann Diagn Pathol. 2003;7:87–94. doi: 10.1053/adpa.2003.50019. [DOI] [PubMed] [Google Scholar]
- 271.Lee SC, Hwang KP, Tsai WS. Detection of Enterobius vermicularis eggs in the submucosa of the transverse colon of a man presenting with colon carcinoma. Am J Trop Med Hygiene. 2002;67:546–548. doi: 10.4269/ajtmh.2002.67.546. [DOI] [PubMed] [Google Scholar]
- 272.Klausner JD, Kohn R, Kent C. Etiology of clinical proctitis among men who have sex with men. Clin Infect Dis. 2004;38:300–302. doi: 10.1086/380838. [DOI] [PubMed] [Google Scholar]
- 273.McMillan A, Gilmour HM, Slatford K, McNeillage GJ. Proctitis in homosexual men: A diagnostic problem. Br J Vener Dis. 1983;59:260–264. doi: 10.1136/sti.59.4.260. [DOI] [PMC free article] [PubMed] [Google Scholar]


